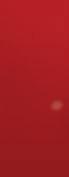

![]()





































It’s hard to believe Santa’s midnight ride is less than a week away. e hustle and bustle of the Christmas season is in full swing at our Webb Weekly o ce. I love getting a preview of all the children’s artwork as it comes in for our Annual Blaise Alexander Christmas Fun Coloring Contest. e e ort the kids put into their coloring is amazing. ey come in from the little ones in three age groups: 4 and under, 5-7, and 8-10. I still can’t color within the lines.
A er all these years of the contest, I still don’t know if Editor Steph does the right thing by enlisting elves from the North Pole to help her with the event. is year, she’s got Jazzy Brightbells, Noel Hollyu , and Jingle Snowsparkle running around the o ce. I o en worry they’re going to get under my feet; heaven forbid I step on one. I also worry that with the long, hard hours Santa works them at the North Pole, one or all of them might defect and disappear. You know, like a Cuban Little League coach has done during the World Series the last couple of years. I certainly don’t want Santa putting me on the naughty list.
A tip of my Santa hat with the American

ag on the side and a Merry Christmas to Blaise Alexander and his family. ey have been on board for as long as I can remember, and I know Blaise appreciates the kiddos’ hard work on all the artwork.
A sincere thank you and Merry Christmas to all the great sponsors who provide the prizes for 10 winners in each age group. Top prize being a $200 gi card to Fly World and Kaos, which is a great place to take the young ones during the Christmas break to burn o a little energy.
Editor Steph will have the winners in next week’s December 25th edition, as well as a list of all the children who entered.
e other o ce event coming to a Christmas close is our annual ringing of the bell for the Salvation Army Williamsport in remembrance of Dave Sechler. If you haven’t stopped and made a donation or mailed one in, please remember we must receive it by December 23rd. We still have plenty of co ee mugs lled with Christmas candy for those that drop in.
I’ll forewarn you to watch out for the elves as they usually come out from the back room as Jaimie’s ringing the bell.


A heartfelt thank you and Merry Christmas to all who have helped carry on Dave Sechler’s lifetime of work. I think the last time I saw him ringing the bell was at Kmart, and of course, he had a big smile on his face.
I’ll nish things out this week with another big-buck-down story. I stopped for my morning breakfast at Dolly’s Diner in Montoursville, and Vickie McKibben had something to show me. e proud grandmother wanted to share a picture of her 13-year-old grandson, David Graf.
David, from Liberty, was a little upset when school was canceled, postponing his basketball game. e snow, however, provided the perfect backdrop for this picture of his monster nine-pointer, sporting a 22-inch spread. e whitetail uno cially scored 152 2/8.
Dave was hunting his family’s land in Liberty and would like to give a special thank you to his stepfather, not only for the opportunity that presented itself that late Wednesday a ernoon but also for all the hunting time they share together.
Great job, young man, and way to hold those crosshairs steady on your


6.5 Creedmoor. anks again to Vickie for sharing. I always love hearing those hunting stories.
Our 17th Annual Webb Weekly Uncle Ron’s Monster Buck Contest runs right through the second season, which begins on December 26th. Full details can be found on page 59.
Well, I’ve got to run and nish a little Christmas shopping. Please get out and about and enjoy all the holiday happenings that can be found in the pages ahead. Let’s all be careful out there.
God Bless America.







































Founder James Webb Sr. 1944-2012
Publisher/Sales
James A. Webb Jr. jwebb@webbweekly.com570-337-0755
Editor Steph Nordstrom 570-337-0759 editor@webbweekly.com
Advertising Sales Staff: Charlie Gizenski cgizenski@webbweekly.com 570-419-3334
Classified Sales
Jaimie Hoover classifieds@webbweekly.com
Production/Graphic Design
Wes Sones webbads@webbweekly.com
Production/Web Development
Curt Musheno cmusheno@webbweekly.com
Larry Andrews General Manager – Retired
280 Kane St., Suite 2 South Williamsport, PA 17702
PHONE: (570) 326–WEBB FAX: (570) 326–9383
By Steph Nordstrom
Well, y’all. This is it. We are down to the Christmas wire! Before you ask, no, I’m still not ready. I will be. Promise. I’m just not there yet.
In the meantime, let’s talk about the final days of the holiday season. There is still plenty of fun to be had and things to do in the days leading up to Christmas. If, unlike me, you are ahead of the Christmas game, now is the time for you to sit back, relax, and enjoy some Christmas cheer!
If you aren’t sure what Christmas cheer to celebrate or where to find it, don’t worry—I’ve got you covered.
Wednesday, December 18th:
Junior League of Williamsport will host their Holiday Auction at 6 p.m. at the Community Arts Center. Tickets include finger foods, entertainment, and more! If you are unable to join them in person, you can still bid online and support our event. Purchase tickets at JLWilliamsport.givesmart.com
Thursday, December 19th:
Since 2012, Williamsport Area High School students have come together to help make the dreams of sick children from the Greater Williamsport area come true. When a wish is granted, a child replaces fear with confidence, sadness with joy, and anxiety with hope. The majority of wish kids go on to overcome their critical illnesses, and research shows that a wish can help children build the physical and emo-

tional strength they need to fight, giving them a better chance of surviving and thriving. This year, the commUNITY: Make-A-Wish Benefit Concert will be held on Thursday, December 19th, at 6:30 p.m. at Williamsport Area High School. Enlisting the help of students from the area, this inspirational concert will feature singing, dancing, and a whole lot of fun. This is a donation-based event, and the concert is free for the public to attend. We hope to make more children’s dreams come true than ever before, but this is something that cannot be done without your help!
Friday, December 20th:
Come see Santa at Blaise Alexander Subaru, 595 Alexander Drive, Muncy. Bring the kiddos for a Santa Claus Meet and greet! They will have coloring books and cookies for some jolly, good fun from 5 to 7 p.m.!
Pull out your ugly sweaters and head to the Bar on Market! DJ KEii will be spinnin’ from 10 p.m.-1 a.m.
Ebenezer Baptist Church will hold its “Ball of the Fall – Snowflake Soiree” at the Scottish Rite at 6 p.m.
Dress in your ugliest sweater or anything festive. And come party with Trifecta Bar and Grill in Montoursville. Live music from Izzy Butters Live Acoustic will also be there, starting at 6 p.m.!
Saturday, December 21st:
Breakfast with Santa, 8-11 a.m., at the Zafar Grotto, 381 E 2nd Ave., South Williamsport. Bring the kids to the Grotto to have breakfast with Santa and get a gift bag.
The jolly ole elf himself is coming to Rosko’s Brew House on Saturday, December 21st, at 1 p.m. The first 50 children will receive a candy and sticker from Santa Claus. Bring your phone for pictures. This encounter gives you one last chance to see Santa before he heads back to the North Pole to deliver presents to all the good boys and girls!
The 3rd Annual Straggler’s Ball! This year, Kimball’s Pub is extending the stage to even more of their talented friends, and proceeds will go towards Milo’s Mission. Milo is a 4-year-old from Montoursville who has Adrenoleukodystrophy disease (ALD). Milo has undergone a bone marrow transplant and continues treatment at the Children’s Hospital in Philadelphia. The Marchese family has been close to many in the Straggler family for a long time. This event has continued to gain momentum each year and is a celebration of family, friends, and live music. Come support the Marchese family and another year of stragglin’. Them Blue Cats 4:30-5:30 p.m.; Green Divide 6-6:30 p.m.; The Sylvan Dell Stragglers 7-8:30 p.m.; Gray Valley 9-??
If holiday prep has you not wanting to cook another thing, be sure to head to New Trail Brewing. They will be hosting Cousin’s Maine Lobster from noon to 8 p.m. There is Nothing better to take the edge off of holiday stress than a beer and lobster roll!
You’ll end up on the naughty list and being beaten with a broom if you miss the Downtown Krampus Crawl! “Come one, come all! Bring the kiddos to see the creepier side of the holidays! We will have treats and trinkets for them all! Come take pictures! Ask about the lore! Dress up with us and parade around town






















































































in a creepy holiday fashion! Yule, be sorry if you don’t! We will be starting at Brandon Park in the parking lot next to the stage. The next stop is the Little League statues on Market St. Then up to the Bar on Market. Next, find us at the fountain outside the courthouse and the Whiskey Room. After that, we will crawl over to the Back Alley Bar to play some giant Jenga. Then, hopping on over to the Bullfrog. And last but not least, checking out the new Jackass Brewery!” The fun starts at 5 p.m. Brunch with Santa! From 11:00 a.m. to 3:00 p.m., at Horsepower Harley-Davidson, 1910 E. 3rd St., there will be plenty of holiday cheer and fun! Snap a FREE picture with Santa himself, and there will be big savings throughout the store!
Have breakfast with Santa at Haywoods Bar & Grill Muncy, 113 W. Water St., Muncy. Saturday, December 21st, from 9-11 a.m. and Sunday, December 22nd, from 9-11 a.m. Reservations are not required but highly recommended. Give them a call to reserve your table today! 570-546-1011!
Sunday, December 22nd:


New Covenant United Church of Christ, 202 E 3rd St., Williamsport, invites you to a no-rehearsal Christmas Pageant. Costumes will be available for those who wish to participate. The service will be streamed on Facebook and YouTube and available in person. It is at 1045 a.m.
If you need to decompress from holiday stress, welcome the Winter Solstice with some candlelight yoga at Tula Virya Yoga, 1764 E. 3rd St., Williamsport, at 5 p.m. Let the warm
glow of candlelight soften the chill as we enter the beginning of the winter season. A gentle flow with ample time for savasana is planned. Bring your favorite mug to enjoy a cup of warm tea—$20 drop-in. Reserve your spot via text or call 570.540.1870.
Join the Hughesville Volunteer Fire Department, 30 South Railroad St., Hughesville, for Breakfast with Santa! From 7:30 a.m. to 12:00 p.m., Come enjoy a delicious all-you-caneat breakfast buffet. Then, Santa himself will come to visit and hang out with us to see all the good boys and girls before he heads back to the North Pole to prepare for Christmas! Pancakes, sausage, bacon, home fries, eggs, toast, and beverages will be available. Takeout will be available.
Tuesday, December 24th:
There are plenty of Christmas Eve services throughout the area, including: – Trinity Episcopal Pro-Cathedral, 844 W. 4th St., Williamsport, will hold two Candlelight Christmas Eve Services with Holy Communion on Tuesday, December 24th at 6 & 9 p.m. The 6 p.m. service will include the children’s program, and the 9 p.m. service will include traditional carols. Nursery care is available during the early service.
– New Covenant United Church of Christ, 202 E 3rd St., Williamsport, at 7 p.m., will host a meaningful service with scripture and stories of the true meaning of Christmas, as well as a candlelight time to sing carols. – Pine St. UMC, 441 Pine St., Williamsport at 9:30 a.m. Bring the whole family for a joyful Christmas Eve morning in Wesley Hall! Ar-



rive early to enjoy donuts and refreshments, then join us for a one-of-a-kind, kid-focused service that brings the Christmas story to life through all five senses. With hands-on elements, lively storytelling, and plenty of room for little ones to move around, this service is designed to engage young hearts and minds in the wonder of Christ’s birth. Or at 8 p.m., end Christmas Eve with a serene and traditional candlelight service in the Pine Street Sanctuary. Featuring scripture readings, beloved carols, and special music, this service is a time for reverence and reflection as we celebrate the miracle of Christ’s birth. Gather with us in the peaceful glow of candlelight for a meaningful, beautiful night together.
– At 6 p.m., CitychurchPa, 36 E. 4th St., Williamsport, will host a time of celebration, and we come together to worship our savior’s birth. Candlelight service to close.
– All Saints Episcopal Williamsport, 1656 Scott St., Williamsport, will have their candlelight service at 9 p.m.
First Church Williamsport, 604 Market St., celebrates the joys and traditions of Christmas in community. This service is traditional in style and worship: a brass ensemble and organ accompany our chancel choir, leading the hymns that anticipate the coming of Christ. Scripture, prayer, a brief message, and candle lighting are also included. Identical services will be at 3 p.m. and 5 p.m.
– Hope River Church, 325 Thomas St., Jersey Shore – join us for this inspiring Christmas Eve service. Our service at 7 p.m. will be filled with music and singing by candlelight. They will also have a special service of hope as they bring in Christmas Day. Starting at midnight on Christmas Eve, they will celebrate the
heart and hope of Christmas in this service.
– Join Pine Street United Methodist Church at 5 p.m. and celebrate Christmas Eve under the glow of twinkling lights and candlelight in Short Park! Surrounded by festive decorations, we’ll sing cherished carols, hear the Christmas story, and bask in the beauty of the season. With cookies, hot cocoa, and a warm community, this outdoor service offers a unique, heartwarming way to celebrate the birth of Christ. Bundle up, bring a chair or blanket, and join us for this special candlelit evening!
– Join Muncy Christian Fellowship, 28 Brummer Pond Rd./East Penn St., Muncy, to sing Christmas songs, short message, and candlelight as we prepare for the Birth of our Savior Jesus Christ. Service is at 6 p.m.
Finally, we are down to the last minute for entry into our Blaise Alexander Christmas Fun Coloring Contest! Jazzy Brightbells, Noel Hollyfluff, and Jingle Snowsparkle have been hard at work sorting and filing all the contests! We have gotten a ton already, and I’m sure they will be coming in HOT this week! Be sure to get entered! We have a lot of great prizes! Remember, 1st place in each age group wins a $200 gift card to Kaos Fun Zone! Imagine all the fun you could have this winter with that!!
As you can see, there is plenty to keep you busy in the final run-up to Christmas! Unless you are me. I have no business doing anything other than prepping for Christmas. If you see me doing anything else, mind your business unless you are willing to help!
Now, if you’ll excuse me — I have shopping…and wrapping…and grocery shopping…and cooking to do!







































































Losing someone special can make the holidays particularly difficult. Feelings of sadness and loneliness may intensify, making the need for support even greater. Instead of avoiding your grief, embrace your feelings, as grief is a reflection of love. Remember, you are not alone during this time of year.


Michael R. Lingg, Supervisor A Tradition of Excellence Since 1879
1914 Memorial Ave • Williamsport, PA 17701 • 570-323-7717
E-mail: KCFH@knightconfer.com • www.KnightConferFuneralHome.com

By Joseph W. Smith III
Charles Schulz’s beloved Peanuts has inspired no less than 50 different television specials; but of course, the best and most beloved is the one that started it all: A Charlie Brown Christmas
Last week in Webb, I named that as my single favorite holiday movie; so now let’s expand a bit with background and trivia on this very special special:
Having launched in 1950, Schulz’s daily newspaper strip had become a cultural institution by 1965. Producer Lee Mendelson was working on a documentary about the Peanuts creator when Coca-Cola reached out about a Christmas special for TV.

already lined up jazzer Vince Guaraldi for his movie’s score, along with Bill Melendez for some animation. The producer gave a “yes” to Coke, even though he hadn’t yet talked to Schulz or Melendez.
Phoning the former, whose childhood nickname was Sparky (ironically, after a comic-strip character), Mendelson told him, “I think I may have just sold a Charlie Brown Christmas show.”
“And what show might that be?” Sparky asked.
“The one you need to make an outline for tomorrow,” said Mendelson — and the two of them promptly laid out a makeshift plot that remained the same throughout the busy sixth-month production.
Though that documentary — A Boy Named Charlie Brown — never actually aired, it was key to launching the Peanuts on television: Mendelson had
The Mexican-born Melendez, who had done cartoon work for Disney and Warner Bros., wound up handling all the Peanuts specials. For this first, he produced over 13,000 drawings. So:
See REVIEWS on Page 10

~ Week of ~ December 9th – December 13th
Eugene A. Young, Sr., 88, of Williamsport
Virginia L. (Hopkins) Buck, 94, of Brookside
Arleen M. Losch, 61, of Lock Haven
Gloria J. Persun, 75, of Watsontown
Cynthia “Cindy” Pearl Bauman, 74, of Williamsport
Patrick John Callahan, 67, of Plunketts Creek Twp. Lewis Kough, 106, of Williamsport
Albert Lee Mills, Jr., 64, of Lock Haven
Beverly M. Worthington, 86, of Pennsdale
E. Lucille Splain, 88, of Danville
Margaret L. Bird, 98
James I. Miller, 92, of Mill Hall
Charles Thomas Laudenslager, 89, of Williamsport
Carl E. Ulsamer, 73, of Williamsport
R. Eldon Metzger, 84, of Williamsport
Sherry A. (Rall) Frisch, 74, of Williamsport
Bertha H. (Jenkins) Thompson, 97, formerly of Williamsport
Marlene Beck Dietz, 89, of Muncy
Ronald W. “Ron” Wertz, 70, of Muncy
Veronica A. Saar, 93
Kenneth B. “Ken” Poorman, Sr., 89, of Williamsport
Sharon R. (Seitzer) Ladson, 71, of Cogan Station
Annabelle E. Temple, 97, of Lewisburg
Raymond “Ray” C. Snyder, 78 of Wellsboro
Harold L. Biichle, 99, formerly of Duboistown



































































None of the artwork in those shows was done by Schulz, who recognized that animation required a special set of skills he did not have.
Meanwhile Guaraldi, whom Mendelson first contacted after hearing the pianist over his car radio, adapted existing music from the doc (including “Linus & Lucy”); he also added versions of familiar carols — some recorded with a children’s choir from a California church.
And Guaraldi likewise composed the brand-new songs “Skating” and
“Christmas Time Is Here.” As production was coming down to the wire and a set of lyrics was needed for the latter — now pretty much a holiday standard — Mendelson jotted down a few stanzas “in about fifteen minutes on the back of an envelope,” the producer recalled.
Though Guaraldi died at only 47, he did score the first 15 specials; and Charlie Brown Christmas remains the second-best-selling jazz album ever (after Miles Davis’s Kind of Blue). One other trivia note: For bass and percussion on the album, Guaraldi was accompanied

by different musicians than those on the actual TV soundtrack.
And speaking of sound: Sparky absolutely refused to allow a laugh-track, though this was industry standard at the time. Likewise, Mendelson and crew broke with tradition by having actual children do the dialog, rather than adults as in most cartoons of the day.
In fact, six-year-old Cathy Steinberg, who played Sally, was not yet even able to read — so Melendez fed her the lines one at a time! There was also a moment of triumph when casting agent Hazel McMillen found their Linus: Christopher Shea, whose “slight lisp gave him a youthful sweetness while his emotional delivery gave him power and authority as well” — in Mendelson’s words.
Snoopy was handled by Melendez, who spouted gibberish and then sped up the tape.
Remarkably, despite a very active young cast, all the vocals were nailed down in a single day, with Jefferson Airplane — who were recording next door — dropping over to get the kids’ autographs.
But initial response to the finished product was less than enthusiastic.
As Wikipedia puts it, “All involved believed the special would be a disaster.”
In fact, after an initial screening, CBS execs complained so stridently that,


Mendelson said, “I really believed, if it hadn’t been scheduled for the following week, there’s no way they were gonna broadcast that show.”
Fortunately, they were all dead wrong. The special premiered on Dec. 9 in The Munsters’ time-slot, coming in second in viewership just behind Bonanza — a success it sustained throughout the coming decades. Critics raved, calling it “fascinating and haunting,” “a yule classic” and “the dramatic highlight of the season.” The Washington Post summed it up nicely: “natural-born loser Charlie Brown finally turned up a real winner last night.”
The show went on to win an Emmy and — another cool tidbit from Wikipedia — the business with Charlie Brown’s real tree “practically eliminated the popularity of the aluminum tree, which was a fad at the time.”
Having shown on regular television for 57 years, the special is currently available for viewing only on Apple TV. But of course, the DVD makes a nice affordable gift — for those of us who still have a player!
As Mendelson might say: It’s fun for all … that children call … their favorite time of year.
(For this piece, I’d like to express my debt to Mendelson’s wonderful and profusely illustrated book on the making of this special.)
















































By Larry Stout
ruth to be told, there really is no way to please everyone.
Take the weather, for instance.
Imagine that it is summer, and it is a bright, sunny day. Is this weather good? I enjoy a nice, warm, sunny day, so I am quite happy. On the other hand, a farmer who might be desperate for rain to save his crops would be very unhappy. e weather is neutral; it is our perspective that makes something good or not so-good and even downright bad.
Politicians struggle with nding that ‘sweet spot’ of doing what is best for their constituents. ere are some political actions, such as President Biden’s pardon of his son, that only the absolute die-hards could justify. But, generally, in government, it is impossible to please all of the people all of the time, as we see close to home —
Lycoming County: e commissioners did the impossible and created a budget that will not require a tax increase. is certainly seems like good news. However, this also requires a number of services and organizations to pull their belts much tighter. e pre-


vious LyCo commissioners focused on improving future growth for the county, which pleased some and disappointed many more. But now, given the current status, a number of the county departments and other agencies supported by the county will have to struggle to do more with less.
At the same time, some projects have been in the works for some time now that absolutely need to be addressed. One is the Williamsport levee, which is almost a century old now.
In the 1930s, the depression was particularly bad in Williamsport, even getting the reputation as the “hardest hit city in Pennsylvania.”
e levee has saved the city through several oods since that time, but it











































needs a number of improvements to be able to be re-certi ed by the Corps of Engineers. And it isn’t cheap; at the last meeting, the commissioners had to approve $1,589,000 for Williamsport Levee Cross Pipes Phase 1 (!!) e other new event in the works is a reassessment of property in Lycoming County. e initial assessment process will take three years, and residents will see changes in their bills in March of 2028. From this reassessment, one-third of the residents will see no di erence, one-third will see their home value drop, and one-third will see their home value go up. Guess which of these three categories will not think it is a good day?
Pennsylvania: Pennsylvania Governor Josh Shapiro signed the state’s budget for scal 2025 into law on July 11. e enacted budget provides $47.6 billion in general fund appropriations for scal 2025, representing a six percent increase over scal 2024 spending. is is $3.3 billion more than anticipated revenues, which will add to the structural de cit the Commonwealth already faces. And it will result in new debt that will take decades to pay o .
Where is all this spending going? Not surprisingly, it goes where there are lots of voters. A big increase is going toward the mass transit SEPTA in Philadelphia and PRT in Pittsburgh. Even though these have seen steep declines in trav-




eler usage in the last ve years, Governor Josh Shapiro plans to spend $282.2 million for these agencies, mostly to SEPTA.
For years, Republicans in Harrisburg have been pushing for a guardrail on spending growth—namely, the Taxpayer Protection Act (TPA). is amendment to the Pennsylvania Constitution was proposed by State Representative Ryan Warner back in 2017. e proposed constitutional amendment would limit the rate at which the Commonwealth’s spending may increase based on the sum of the percentage increase in the Consumer Price Index and population growth each year.
Enacting the TPA would keep state expenditure growth in line with Pennsylvania taxpayers’ ability to pay. Moreover, TPA would not require spending cuts but rather slow the expenditure growth rate. Had TPA gone into e ect in 2019 (right before in ation went o the charts), state spending for FY 2024–25 would have been $41 billion, and Pennsylvania would have a $2.8 billion budget surplus. Enacting TPA now would help prevent future budget de cits by ensuring that government spending grows responsibly. Imagine only spending what you have. And as far as the federal government, well, let’s wait and see on that one. Otherwise, have a nice day!



































































































































































































By Lou Hunsinger Jr.






If you were in downtown Williamsport during the Christmas season in the 1980s, you might have seen or bumped into Sylvia DiMassimo — only you didn’t know it. She portrayed Santa Claus at Santa’s House there during that period. The experience provided her with fond and warm Yuletide memories.
appropriate outfit on inside, upstairs of the then-known Troisi Men Shop. I had a few funny moments going into the store to get ready from male shoppers who were looking at me as I would go into the dressing room and come out dressed as Santa! Many good laughs!” said Sylvia.
She said portraying Santa sometimes presented some interesting and perhaps vexing ethical challenges for her.




“I had the opportunity to have a part-time position working for, at that time, known as The Williamsport Downtown Association as the seasonal Santa Claus. I was a single mother by this time and had gone back to WACC (now Penn College) to further my education. I was asked if I would be interested in this position for the, I believe the 1981 Christmas season. Well, being a woman, who would think I’d have an opportunity like this? At this time, the Pine Street area was closed from traffic from Third Street to Fourth Street,” Sylvia told Webb Weekly.
She cited the most amusing part of the job for her. “The funniest part of the position meant I had to get my
“In the evenings, at I would go heading to ‘my’ house, the children would already be lined up to tell Santa what they wanted for Christmas. With this in mind, I was not so sure about them getting the items that they wished for. As a mother of two children myself, I could relate to most of the things that were asked for — the usual wishes like trucks, doll babies, bicycles, etc. However, being able to tell that some may not receive such gifts, I had to be very careful not to promise them that Santa would deliver the wanted items. You don’t realize how a broken promise from Santa could break these darling little ones’ hearts. I learned very early to let them know that Santa will try to
See DOWNTOWN SANTA on Page 16





































































































Apartments



The Williamsport Apartments offers pet-friendly, easy living to individuals 55+ who are looking to live a worryfree lifestyle with all the comforts of home.
In addition to providing home maintenance, lawn care and snow removal, our full-time Wellness Coordinator offers health and fitness classes and organizes activities to keep residents healthy, active and engaged.
Our apartment buildings feature a resident dining room, lounges, card rooms and other recreation areas. Enjoy as much privacy or as many social opportunities as you like. We offer several apartment floor plans and options to meet your needs.
do the best I can and make sure they get some wonderful gifts under their tree. I had a friend who was a helper and would be there to help in any way I may need,” declared Sylvia. Her Santa work, though rewarding, sometimes saddened her but reminded her that the full blessings of the season don’t come to everyone.
“As the evenings went on, many children would come every night. Some with no socks on, hats, or gloves. Believe me, there were some cold, cold nights, and a Candy Cane may have been all they had for that night. It was very emotional for me to see them doing without such needed items that, as a mother, made sure my children were safe, warm, and well dressed for the season,” Syliva noted. “This gave me the most heartbroken feelings for some of these children. My helper would go into one of the five and ten stores almost every night, and I would buy gloves and hats to keep in the hut to give to the children who obviously needed them and were cold. Some would ask if they could come in just to get warm or they remembered something else they wanted to wish for. Sometimes, Santa would tell them to come back later, and Santa would make
them some hot chocolate. I would have cookies, too, that I’d bake at home after classes and before I needed to report to duty! I would buy hot chocolate in the stores when they would get there. Again, I tell you the most heartbreaking yet rewarding times were when I knew, not just Santa, but that I made a child my friend that I knew was less fortunate than many. Then, the time came for the season to be over. Christmas was coming, and Santa had to go back to the North Pole to get Rudolph and the other reindeer ready for the big night. From the big day, Santa arrived with the downtown parade until Santa went back to the North Pole to prepare for his/her big night, my heart prayed that those children who visited Santa would be blessed and hopefully received some Christmas presents that made them fulfilled with the love of the Reason for the Season, Jesus Christ, our Savior was born.”
People like Sylvia DiMassimo are reminders of what is best about the Christmas season. These earthly angels do their best to make things a little better for others and that we should all strive to make a difference in our own ways throughout the year, not just during the Christmas season.






Note: This article is in a series called Two Roads. Previous articles are always available at www.webbweekly.com.
Then, the eyes of both of them were opened, and they realized they were naked, so they sewed fig leaves together and made coverings for themselves. Genesis 3:7
Measure twice and cut once. Alistair Macleod
When Adam ate the forbidden fruit, instead of confession, he first chose an
attempt to fix the mistake. That made sense to him.
That makes sense to us, too. There are mistakes we can fix. If you don’t cut a board short enough, you can fix the mistake by measuring and cutting again. There are, however, mistakes we can’t fix. Once a board is too short, cutting it again won’t fix it. For Adam, when he ate the forbidden fruit, he cut the board too short, and when he tried to fix his mistake, the board got shorter.

Will Rogers gave us another adage that fits here, If you find yourself in a hole, quit digging. If you make a mistake that can’t be fixed, the situation will not improve until you stop cutting and digging. Trying to fix the unfixable will only make matters worse.


fixed anything. It would have resulted in a life of deceit, a child who didn’t look anything like his father, a mother who had to maintain lies for the rest of her life, and a king living in constant fear of exposure. Worst of all, David’s fix would have kept him from confessing his act of disobedience, resulting in a downward spiral on the road to death and eternal separation from God. Here’s the hard truth: a disobedient choice cannot be fixed; it can only be redeemed. Redemption is a work of grace. We can’t redeem ourselves. We can’t fix our problems. Our hope isn’t found in us and our self-destructive solutions; it is found only in the redeeming grace of God through Jesus Christ.






































Adam’s fix for his shameful nakedness was covering himself with fig leaves. It made him feel better knowing he wasn’t naked anymore. Adam thought being naked was the problem, so he fixed it, but being naked wasn’t his problem. The fact that he knew he was naked was the problem. Eating the forbidden fruit opened a door of knowledge he could never shut again. There was nothing he could do to unknow what he now knew. He broke God’s command. Shame was a symptom of the real problem — disobedience. His innocence was gone, and anything he did to fix the mistake just made the board shorter and the hole deeper.
King David’s effort to fix his moral failure was to have Uriah come home and sleep with Bathsheba. Even if his plan had succeeded, it wouldn’t have







I have watched too many fallen men cause further damage to their wives and children while trying to fix a mistake. Some of them are adulterers who think being a super-husband will somehow fix the past. Adultery is a mistake that can never be fixed; it can only be redeemed. Others were gamblers who put their family’s financial security in jeopardy. Their attempt to fix the problem was to place another bet and cut the board shorter. A few of them were abusive fathers who tried to fix the bruises and emotional scars by buying extravagant gifts for the child



















they injured. Fixing never works — the hole just gets deeper.
Hear this: we cannot fix moral failure and can never reverse the damage done. A broken bone is broken forever. Have you ever broken a bone? If you have, then you know that bone is different from the rest, and the memories of the injury are permanent, no matter how well it has healed.
When I was in fourth grade, I ran face-first into a handrail while playing tag with friends and shattered my two front teeth. The dentist repaired them with caps, but the damage was done. I had to get those caps replaced when I was a senior in high school and again about ten years ago. Those teeth will never be the same as the rest, and time will never change that fact.
A moral failure permanently breaks what was once unbroken. It cannot be fixed, but Jesus has hope for us – a moral failure can be forgiven, healed, and redeemed!
The only hope for a fallen man — and it is a great hope — is the journey of redemption. There is nothing else. The sooner a fallen man comes to that realization, the better off his victims will be and the better off he will be. Healing begins for everyone when a fallen man
chooses the steps that lead to redemption. Those steps include humble confession, repentance, and restitution. How can we tell the difference between a mistake that can be fixed and one that can’t? This is an important question because we make mistakes every day.
A mistake that can be fixed is one that does not offend. I do a lot of woodworking. When I cut a board and it doesn’t fit because it is too long, I simply make another cut and say to myself, “No harm, no foul.”
When I cut a board too short, I am offended by my failure. The consequence is the loss of a board, or worse, another trip to the lumber yard, resulting in lost time and money.
A mistake that cannot be fixed is one that offends. It creates harm to someone; it is a foul against them; it causes loss; it hurts. This is why someone who breaks a law is called an offender. Are you trying to fix an offense today? If so, stop. Your efforts are doomed. Instead, take the steps that lead to redemption. God will forgive, your victims will begin to heal, and you will begin breaking the chains of guilt and regret. Today is the best day to begin the journey.





































































ANNOUNCEMENTS
Submit contributions in a
What: When: Where:
format to webbnews@webbweekly.com. View more calendar listings at www.webbweekly.com.
EVENTS
Model Railroad Open House
What: The Clinton Central Model Railroad Club in Castenea, announces their annual open house season. Family members of all ages will enjoy the sights and sounds of trains operating on over 2,300 feet of mainline and branch track on our large HO scale, Digital Command Control (DCC) layout. Station tours including railroad memorabilia in the museum and model railroad displays will be provided throughout the day and evening open houses. Admission and parking are free for all.
When: December 17th, from 5-8 p.m., December 28th, from 10 a.m.-4 p.m., January 7th, from 5-8 p.m., January 11th, from 10 a.m.-4 p.m., January 25th, from 10 a.m.-4 p.m.
Where: Clinton Central Model Railroad Club at 15 Logan Ave, Lock Haven.
Dinner
What: Dinner: black diamond steaks or fish. Open to the public.
When: Friday, December 20th, from 4:30-7:30 p.m.
Where: American Legion Post 617, 901 S. Market St., S. Williamsport.
Dinner and Band
What: Dinner: stuffed peppers or fish. Band Pepper Street. Open to the public.
When: Friday, December 27th. Dinner from 4:30-7:30 p.m. and band from 8 p.m.-11 p.m.
Where: American Legion Post 617, 901 S. Market St., S. Williamsport.

Book Sale
What: Friends of Muncy Library Book Sale.
When: December 28th, 10 a.m. to 1 p.m.
Where: Muncy Library, 108 S. Main St., Muncy.
Band
What: GC and Company. Open to the public.
When Tuesday, December 31st, from 5 p.m.-8 p.m.
Where: American Legion Post 617, 901 S. Market St., S. Williamsport.
Dinner Specials
What: Friday night dinners/weekly specials.
When: Every Friday night.
Where: Milton American Legion, 401 N. Front St., Milton.
Bar Bingo
What: Bar bingo.
When: Every Tuesday night at 7:00 p.m.
Where: Eugene Grafius American Legion Post 104, 1312 Broad St. Montoursville.
Toastermasters Class
What: Control your fear of public speaking. Practice speaking before a friendly audience who will guide you on your journey to becoming a better speaker. Contact Donna Miller 570-971-0098 or Phil Buehrer 570-3266801.
When: 1st & 3rd Wednesday of each month at 6:00 p.m.
Where: 505 Restaurant, 505 Washington Blvd., Williamsport.
Post Breakfast
What: The Milton American Legion, Post 71, will begin serving breakfast for $9 per person with a large menu available. Please call 570-742-4236 ahead if you are part of a large group so we can be ready for you.
When: First and third Sunday of the month. Breakfast is open to the public from 9:00 a.m.-1:00 p.m.
Where: Milton American Legion, Post 71, 401 N. Front St., Milton.

CHURCH EVENTS
Donation Drop-Off
What: Donations drop-off & set-up of infants & adult seasonal clothing/shoes.
When: Thursday, December 19th, from 4:00-6:00 p.m.
Where: Redeemer Lutheran Church - Curbside drop-off, 1101 Washington Blvd., Williamsport.
Free Lunch at Holy Cross Orthodox Church
What: Free community luncheon.
When: Saturday, December 21st, from 10 a.m.-noon.
Where: Holy Cross Orthodox Church - Fellowship Hall, 1725 Holy Cross Ln., Williamsport.
Daniel’s Closet
What: Daniel’s Closet FREE clothing & shoes - infants & adults.
When: Saturday, December 21st, from 8:30-11:00 a.m.
Where: Redeemer Lutheran Church Social Hall, 1101 Washington Blvd., Williamsport.
Worship Service
What: Worship service entitled, “The Magnificat.”
When: Sunday, December 22nd, at 9 a.m.
Where: Mill Creek Church, 2255 Warrensville Rd., Montoursville.
Worship Service
What: Worship service entitled, “The Magnificat.”
When: Sunday, December 22nd, at 10:30 a.m.
Where: Bethel Church, 717 Kimble Hill Rd., Williamsport.
Bible Study
What: Joint bible study for Bethel and Mill Creek churches focusing on the Gospels.
When: Sunday, December 22nd, at 3 p.m.
Where: Bethel Church, 717 Kimble Hill Rd., Williamsport.
Closet Tear-Down
What: Volunteers needed for “Closet” tear-down.
When: Monday, December 23rd, from 9:00-11:00 a.m.
Where: Redeemer Lutheran Church Social Hall, 1101 Washington Blvd., Williamsport.
Bible Study
What: Joint Christmas Eve Service entitled, “The Christmas Story.”
When: Tuesday, December 24th, at 6:30 p.m.
Where: Mill Creek Church, 2255 Warrensville Rd., Montoursville.
Christmas Eve Services
What: We will hold two Candlelight Christmas Eve Services with Holy Communion. The 6 p.m. service will include the children’s program and the 9 p.m service will include traditional carols. For more information, contact us at 570-322-0126 or trinitychurchpa@comcast.net.
When: Tuesday, December 24th, at 6 & 9 p.m. Where: Trinity Episcopal Pro-Cathedral, 844 W. 4th St., Williamsport.
Worship Service
What: Worship service entitled, “Punished? For doing Right.”
When: Sunday, December 29th, at 9 a.m.
Where: Mill Creek Church, 2255 Warrensville Rd., Montoursville.
Worship Service
What: Worship service entitled, “Punished? For doing Right.”
When: Sunday, December 29th, at 10:30 a.m.
Where: Bethel Church, 717 Kimble Hill Rd., Williamsport.
Bible Study
What: Joint bible study for Bethel and Mill Creek churches focusing on the Gospels.
When: Sunday, December 29th, at 3 p.m. Where: Bethel Church, 717 Kimble Hill Rd., Williamsport.
Tivoli UMC Christmas Service




















What: There will be a covered dish luncheon at noon, please bring a dish to share. The Christmas Service will begin at 1pm. There will be special music. Rev Dr James Behrens will be giving the sermon. The public is invited. Please call Sue Sprout 570-584-4917 with total coming by December 15th so we can know how many to set up for.
When: Friday, December 20th, at noon.
Where: Tivoli UM Church.
Fishers of Men
What: Fishers of Men playing bluegrass, gospel, and holiday music.
When: Monday, December 23rd, at 7:00 p.m.
Where: Sugar Valley Church of the Brethren, 2305 E. Winter Rd., Loganton.
Christmas Eve Service
What: Christmas Eve candlelight service.
When: Tuesday, December 24th, at 7:00 p.m.
Where: Third Street Church, 931 East Third Street., Williamsport. Parking in rear.
His Glory Ministry
What: Weekly Friday night service. Come as you are, and experience the love of Jesus Christ. Bring yourself, bring a friend, all are welcome.
When: Friday nights, at 7:00 p.m.
Where: Hampton Inn, Susquehanna Room, 140 Via Bella St., Williamsport.
Church Service
What: Church service.
When: Sunday morning at 10:30 a.m.
Where: Moreland Community Church, 1300 Church Dr., Muncy.
Church Service
What: Sunday church services.
When: Sunday School, at 10:00 a.m. (March-November), regular worship service at 11:00 a.m. year round.
Where: Haneyville Bible Church, 16655 Coudersport Pike, Lock Haven.
GriefShare Support Group
What: A weekly seminar and support group for people who are grieving the loss of a loved one.
When: Tuesdays at 6:30 p.m. Please contact the church at 570-546-8030 for the most current schedule.
Where: First United Methodist Church, 602. S. Market St., Muncy.
Church Service
What: Messages from the Bible by Pastor Scott Koser.
When: Sunday mornings. Service time 10:30 a.m.
Where: Heilman Community Church, 2792 Kehrer Hill Road, Montoursville.
MEETINGS
Post 617 Meetings
What: Post meetings.
When: Saturday December 21st. Active – 10 a.m., Home Association – 11 a.m., and Auxiliary – 12 p.m.
Where: American Legion Post 617, 901 S. Market St., S. Williamsport.
Bald Eagle Art League Meeting
What: Watercolor Artist Anni Matsick to Present at the January Bald Eagle Art League meeting.
When: Thursday, January 2, 2025, from 6:30-8:00 p.m.
Where: Thomas Taber Museum, 858 W. 4th St., Williamsport.
Legion Meeting
What: Muncy American Legion Auxiliary Unit 268 monthly meeting.
When: Last Monday of the Month at 6:30 p.m.
Where: Roland Ritter American Legion Post 268, 515 Legion Rd., Muncy.
Domestic Violence Support
What: Domestic Violence Support Group suggested for anyone 21 years of age and older who have experienced Domestic Violence.
When: First Tuesday of each month from noon-1:00 p.m., and the third Wednesday of each month from 5:15 p.m.-6:15 p.m.
Where: YWCA Northcentral PA, Park Room, 815 W. Fourth St., Williamsport.
West Branch Pride
What: West Branch Pride.
When: Monthly meeting, 3rd Tuesday of the month, at 7:00 p.m.
Where: YWCA Williamsport.
Phil Reeder Solo Guitar
What: Phil Reeder solo guitar playing acoustic eclectic.
When: Friday, December 20th, at 7:30 p.m.
Where: Sons of Italy Lodge 2786, 144 E. Fourth St., Williamsport.
Keystone Cats
What: Keystone Cats playing a holiday show.
When: Saturday, December 21st, at 1:00 p.m.
Where: Presbyterian Home, 810 Louisa St., Williamsport.
Loose Cats
What: Loose Cats playing rock, pop & country.
When: Saturday, December 21st, at 7:00 p.m.
Where: Windows on 4th, 200 W. 4th St., Williamsport.
Williamsport Youth Choir
What: Williamsport Youth Choir present their Christmas concert On the Shoulders of Giants.
When: Saturday, December 21st, at 11 a.m.
Where: Clarke Chapel at Lycoming College.
Country Line Dancing
What: Country line dancing.
When: Wednesdays from 7:00 p.m.-10:00 p.m.
Where: Woodward Township Fire Hall, Linden.
Ballroom Dance Classes
What: Beginning Ballroom Dance Class for anyone interested in learning to dance. Cost will be $10 per couple per class. To register please call Frank at 570-220-4806.
When: Thursday evenings from 6:00 p.m.-7:15 p.m.
Where: Classes will be held in Hartzel’s Dance Room in Montoursville.
ART EXHIBITS
ART EXHIBITS...
Theresa Crowley Spitler
What: Landscape Artist, Theresa Crowley Spitler show.
When: Through December 31, 2024.
Where: Genetti Hotel’s Windows on 4th, 200 W 4th St., Williamsport.


























It’s been ve years since I have shared why Candy Cane Lane is so near and dear to my heart.
Having a view of that mountain with the street all lit up in my old bedroom window from the age of four till I was thirteen was a big part of it, but then something magical happened years later.
Grab a cup of hot cocoa and come sit by your tree.

Andrea McElroy
Let me tell you about one of my favorite Christmas stories.
I was nineteen years old. Life was good. I was still with my high school sweetheart and working full time. All I knew was that I never had to go back to school, which made me the happiest person alive. I was in love with this very handsome guy named Chris McElroy. I knew he was a keeper.
On December 19, 2004, our lives changed forever. He planned to take me out to dinner that evening. It was strange that he asked on a Sunday. Usually, we hung out at my parents’ house because, on Sunday nights, Momma made us all our famous nachos and cheese — salty nachos piled high with extra sharp cheese. Chris’s rst meal with us on our
rst date back in 1999. He said that was the deal-sealer for how he knew I was the one. I still remember getting ready that night. My momma seemed extra happy — not Christmas excitement happy, but a di erent kind of happiness. Both of my parents saw me o to dinner that night when we heard Chris’s car pull into the driveway. Momma made sure I was dressed warm enough, while Dad made sure to tell us to “drive safe.” He always did and still does to this day.
O we went to dinner at the Olive Garden. Man, I loved it there; I still do! We both ordered the Chicken Alfredo that night, but Chris seemed o . It was kinda strange. Just extra quiet, and then the food came, and he could hardly eat. is was like a rare event because this boy could eat! (Now we have a eenyear-old just like him. Haha. A bottomless pit!) I remember our exact table that night and how the evening went. We had a nice time, but I could just tell that something was o .
We le the OG, and I thought, at that point, we were heading back home. As we were getting up on the highway, he asked if I would like some hot cocoa and


































go look at some lights. I never say no to driving around looking at lights. Lights, especially Christmas lights, make me so happy. I can have the worst day in the world, but if I go out that evening and look at the lights, I forget about absolutely everything. ey seriously make me so happy.
With hot cocoa in our hands, we were driving around Southside, looking at lights, making our way towards Candy Cane Lane. When we got there, Chris pulled over on the lower part of Summer Street, pulled the e-brake, and looked over at me.
“Care to walk up Candy Cane Lane tonight?” he asked.
Now, I haven’t mentioned yet that it was the coldest night! It was seven degrees outside with a windchill that made it negative. I was hesitant, but I said, “Well, it’s freezing out, but I guess I am up for it since you and my momma made sure I dressed warm.” It sounded fun. All these years, I had never walked up Candy Cane Lane. I had only driven.
As we were walking up, the tra c was horrible. Both lanes were lled with joyful seekers enjoying the lights. Little did Chris know that night that they would have a live manager scene, Mickey, Minnie, Goofy, and Mr. and Mrs. Claus there. What a neat experience to walk up that evening. We reached the top, and Chris seemed nervous. I asked


him if he was OK. I thought maybe he was just out of breath from the climb or something, even though we were not walking at a fast pace. He just kept looking around as if he was looking for something. He grabbed my hand, and we walked across the street back down the other side. We get about a quarter of the way down, and he stops in front of my favorite house. He looks at me dead in the eyes and says, “Can you hold this for me, please?” He asked me to hold his































































hot cocoa cup. He reached into his coat, and before I realized what was going on, he got down on one knee. I, completely dumbfounded, finally realized what was going on. All the puzzle pieces started coming together!
“I love you so much. Will you marry me?” he asked.
With my hands covering my mouth, I nodded my head, yes, as all the people around us started clapping and cars beeped their horns.
every year and relive that night over and over again.













































“Yes!!” I said as I wrapped my arms around his neck and kissed him.
It couldn’t have been a more magical setting. It was perfect.
Chris purposely picked a Sunday evening, so there wasn’t anything over there that night. Little did he know that they still had live people on a Sunday evening. We still laugh about it to this day because that made him even more nervous with so many people around.
This December 19th will be our 20th anniversary of this memorable night. We have walked up Candy Cane Lane every year since then. Going to the OG for dinner, stopping for hot cocoa, and walking up Candy Cane Lane.
Our children quickly became a part of this tradition with us, and now it’s a tradition that happens every year. I am so thankful for such a special place to go to

Candy Cane Lane will always have a special place in my heart. Thank you to everyone on that amazing street who gives so many that Christmasy feeling every time we drive up. Merry Christmas, Summer, and Spring Street! It’s that time of year for my Candy Cane Lane Scavenger Hunt. I love how so many of you look forward to this. Remember, this scavenger hunt goes clear to the top of Summer Street and then up to the tippy top of Spring Street. Have a holly, jolly good time, and maybe we will see you later on Thursday evening! Candy Cane Lane Scavenger Hunt
– Can you find six manger scenes??
– Carolers singing “Noel”
– A beautifully lit up carriage
– A gingerbread man greeting at a front door
– A crazy pig in a kayak
– Scooby-doo, where are you!?
– Brightly lit american flag
– Santa in an airplane
– Stocking ferris wheel
– Two penguins on a present
– A golden retriever puppy ice skating
– Yukon Cornelius
– A big red bell
– A moose with a red bow
– Rudoph pulling a lighted sleigh










































By Terri Schlichenmeyer
“Cabinet of Curiosities: A historical Tour of the Unbelievable, the Unsettling, and the Bizarre” by Aaron Mahnke, with Harry Marks c.2024, St. Martin’s Press $30.00
322 pages












Mahnke has a favorite place he likes to visit. It’s so appealing to him that just imagining it makes him happy. It’s the Enlightenment Room at the British Museum in London, and it’s lled with vast shelves of collected oddities.
Three, two, one.
Ready or not, here you come!
So which side was your best Hide & Seek position? Were you the kid who knew all the places to go and never be found, or were you usually “it,” the one who could spot anyone, anywhere, to win the game? Was hiding the greatest part or, as in the new book “Cabinet of Curiosities” by Aaron Mahnke with Harry Marks, was seeking half the fun?

Much like the person who amassed that room full of curiosities, Mahnke ferreted out strange tales for this book.
ere’s the story of America’s “ rst fourteenth state,” and it wasn’t Vermont. It was named a er an American hero you’ll recognize, but it didn’t last long: North Carolina clawed the land back and that was that. You’ll also read about America’s oldest slave, his life, his observations, and his jaw-dropping accomplishment. Read about how our ag came to
Whenever he’s in London, Aaron


See BOOKWORM on Page 30






















For an inspirational concert full of uplifting singing and dancing by the students of Williamsport Area High School

DETAILS
Thursday, 6:30pm, December 19, 2024 at Williamsport Area High School
2990 W. 4th Street, Williamsport, PA
As a community, we create life-changing wishes for children with critical illnesses.


be, the student who fought for it, and what he received for his ght. See why King Louis XVI should’ve just stayed home at least once a month, and why so many classical music composers avoided the number nine. Learn about weird creatures and lightning strikes, see how a potato chip can found a new use, how Braille was developed, why a simple advertisement caught the attention of wartime government o cials, how some radio programs can be super-creepy, and why Civil War soldiers wanted a certain kind of bacteria to grow in their wounds. ese, and a tale about ice, could “be the most chilling part... of the entire story.”
You might think, when you rst snag “Cabinet of Curiosities,” that you’re in for a fun, jam-packed collection of hidden history. And you’d be half right. is book is, indeed, full of enormous enjoyment, laughs, groaner puns, and things that’ll make you
say “WOW!” e stories are addicting. You’ll want to share them with friends and co-workers, knowing that they’ll get a kick out of these tales, too.
Problem is, many of them are apocryphal and incorrect, or at least i y. ey feel as if they came from one of those websites created from embellished stories, or from ller articles in a tabloid or a sensational magazine. Some of the tales here seem, in fact, to be greatly rehashed and may even be familiar – especially if you’re the fact-checking type. And that may set a reader up to make a decision. Do you want to read lighter-sided tall tales that are very entertaining but that may be unreliable, if not downright error-prone... or do you want solid history with your enjoyment? What you prefer should drive your need for this book. “Cabinet of Curiosities” is indeed curious fun, but not if consistent, solid facts are what you seek.

















































a truly remarkable memory, I will go back to the beginning and give you the CliffsNotes version of how our beloved Christmas figure came to be. Oh, just for the record, while I am a fan of cookies and milk, there is nothing wrong with leaving out a couple of crispy New York slices of pizza and a cold beer for Dad, I mean Santa, this year.







ith Christmas almost upon us I thought I’d have a little fun with my column and revisit an article I wrote a few years ago. I’m sure by now you guessed it’s about everyone’s favorite jolly man in a red suit, Santa. I have always found origin stories interesting and how time and circumstance can shape modern interpretations in unexpected ways. The tradition of Santa Claus is no exception. I recently had a table at very successful community event where my main employer was one of the sponsors and, as a parent of grown children, noted the excitement that the kids had when Santa walked into the room. In fact, you would have thought it was actually Christmas morning the way their faces lit up. So, it seems that Santa is going strong after all of these years.
But where does the idea and our modern interpretation of old St. Nick come from? While I am sure all of you read my article years ago, unless you have
He dresses quite strangely though the description changes and eyewitness accounts vary. In some locations he wears big green robes. Other witnesses have him dressed as a dirty figure carrying a stick. Often, however, he as been spotted wearing a flamboyant outfit of red velvet with a matching hat and big black boots. He is probably a type 2 diabetic and may battle high blood pressure, as most accounts describe him as obese, and it is rumored he largely subsists on a diet of cookies and milk. He is a world class cat burglar in spite of his size. Evidence points
See LIVING WELL on Page 34














































































to him breaking into literally millions of homes across the world annually. Some accounts say he is a drinker and a brawler. Still, after all of that, he is one of the most beloved figures in human history.
If you guessed that Santa Claus is our wanted felon, you are partially correct. He is known by many names. In Belgium and France he is known as Pere Noel, in Chile his name is Viejo Pascuero, in the Netherlands it is Kerstman or Sinterklaas. In Brazil he is
known as Papai Noel, in Finland it is Joulupukki, and in Germany his name is Weihnachtsmann or Christkindl. In Italy it is Babbo Natale, in Norway he is known as Julenissen, in the UK he is Father Christmas, and in Sweden he is Joltomten. In Russia he is Ded Moroz, Poland calls him Swiety Mikolaj (St. Nicholas), and in Hungary he goes by Mikulas (also St. Nicholas). Dun Che Lao Ren (Christmas Old Man) is his name in China, Kanakaloka in Hawaii, and Hoteiosho in Japan. He also has

Belts, Handbags, Purses, Wallets, Belt Buckles, Moccasins, Heart Shaped Bells, Carhartt Clothing, Pet Supplies, Tools for the Man, Shoes & Boots for the Entire Family, Wagons, Toys ...

many informal names such as St. Nick, that Jolly Old Elf, Santa, Father Christmas, and Kris Kringle. The list goes on and on with both many formal and informal names. Religious conflict within Christianity, coupled with pagan influences, has mixed and muddied the many versions of this beloved character over the centuries and the origin of some names is debatable.
Darker versions have also sprung up throughout history including Krampus, Knecht Ruprecht and Pelznickel. Krampus was known to be a demon-like monster with horns that stole away the worst of children and ate them in his cave and Pelznickel, also known as Belznickel, is said to dress in dirty clothes or matted firs and carry a switch to beat misbehaving children. These darker versions are a bit scarce in the North America, however, occasionally making appearances at festivals that are usually of a Germanic theme. In Europe, however, they are more commonplace during the Christmas season.


















Though there have been many “Santas” over the years, St. Nick was actually based on a real-life Saint Nicholas who is believed to have lived from 270-343 AD. He was born to wealthy





parents in the village of Patara which is now part of Turkey and was known to be generous and protective of children. A recurring story tells of a father that had three daughters but was too poor to offer a dowery so that they could be married. This was very significant in those days and meant that the girls would likely fall into a life of prostitution as their only means of survival. Hearing this he provided the three girls with dowries by throwing gold




































through an open window. It is said that the gold landed in shoes or stockings that had been placed by a fire to dry, thus beginning the tradition of placing stockings on the mantle by a fireplace. His generosity was boundless, and he is reported to have used his entire fortune to help the sick and the needy.
Nicholas was known as such a devout Christian that he was made Bishop of Myra, an area that has changed hands many times but is now in present-day Turkey. He is said to have died on December 6th, 343 and because of his love of children, the tradition of giving gifts in honor of the death of St. Nicholas became custom. December 6th remains as a day of gift giving in many European countries to this day.
Like his name, the look of Santa Claus has changed many times but the modern image of a portly older gentleman with a beard and spectacles was popularized in North America by the 1823 poem, “A Visit from St. Nicholas” better known as “‘Twas the Night Before Christmas” which was published anonymously in 1823. The poem was later attributed to Clement Clarke Moore, who claimed authorship in 1837. It was later contested that the true author was Henry Livingston, Jr., who penned the

poem which was supported by content analysis, though credit for the piece is still generally given to Moore.
The image was further strengthened by cartoonist, Thomas Nast, with an 1881 illustration in Harper’s Weekly. This drawing became so popular that it is still reproduced today and has cemented our image of modern-day Santa Claus that is used in celebration and advertising around the world.
‘Twas the night before Christmas, when all through the house not a creature was stirring, not even a mouse.
The stockings were hung by the chimney with care, in hopes that St. Nicholas soon would be there...
Regardless of where you are from, what you call him, or what you believe he looks like, Santa Claus has had a profound impact upon the season of Christmas throughout history. He is a character that brings joy to children and signals the anticipation of Christmas morning. For adults, he reminds us of a simpler, more innocent time. He is part of the magic that remains in this fast paced, digital world and allows us to forget our troubles for a brief moment.
Oh, by the way, he IS real!














































































































































































On December 7th, the Lycoming Clinton County Homeschool Association (LCCHA) held its 1st annual Homeschool Science Fair at the Pine Street Methodist Church in Williamsport. The event occurred between 2 and 4 p.m. with 29 participants in three age groups (5–8-yearolds, 9–12-year-olds & 13+). Students were given parameters to work under, which included a question to answer, a presentation board, and an interview by three judges.
The judges were from a variety of backgrounds within the world of science. They included retired physician Don Hess, current physician assistant Dan Barker, Gun Smith Tom Richardson, retired public school teachers Shelly Helm and Beth Robinson, engineer Josiah Covert, Penn College horticultural student Lila McKeon, The Bloomsburg Children’s Museum director Ginny Weibel, and Retired Penn College instructor MaryAnn Banks.
The LCCHA community is thankful for their dedication and commitment

Winner for 1st place
to support science in our youth. They had prizes and gifts donated by Camp Susque, Backhouse Café, Clyde Peeling’s Reptiland, The Children’s Museum, and Kaos Fun Zone. Prizes were awarded for 1st, 2nd, and 3rd place in cash and tokens from our donors.
They also had a People’s Choice Award, in which the student won $50, and a microscope that a private individual donated.
Topics ranged from plate tectonics to inhabiting Mars and the science of storytelling. All participants were interviewed three times and scored by each judge based on topic choice, presentation, and use of the scientific
See SCIENCE FAIR on Page 40




















































If you are 60 years of age or older, stretch your grocery monies by coming to dine with us!
We offer a hot meal and “Lighter Fare” menu options.
Come dine with friends or make some new ones!
Reservations are required 48 hours in advance. Transportation can also be arranged!
Contact your nearest Center for Healthy Aging to make a reservation or for more information!
Clinton County Community Center 124 East Walnut Street Lock Haven 570-858-5822
Jersey Shore Center 641 Cemetery Street Jersey Shore 570-601-9591
Lincoln Center 2138 Lincoln Street Williamsport 570-601-9573
Centers for Healthy Aging
Loyalsock Center 1607 Four Mile Drive Williamsport 570-601-9590
Meck Center 50 Fitness Lane Muncy 570-601-9593
Save the date for these upcoming events!

Mill Hall Center 9 Peale Avenue Mill Hall 570-726-6378
Renovo Area Center 415 Fourth Street South Renovo 570-923-2525
RiverWalk Center 423 East Central Avenue South Williamsport 570-601-9592
www.stepcorp.org/Center-Calendars
MondayTuesdayWednesdayThursdayFriday
December 23
Beef roll-up with gravy, whipped potatoes, creamed spinach, Mandarin oranges, dinner roll
Lighter Fare
Ham & bean soup, chef salad with ham, turkey, and cheese, fruit cocktail, macaroni salad, fresh orange
December 30
Cheddar cheese omelet, hot spiced peaches, Harvard beets, pumpkin custard, whole grain bread
Lighter Fare
Beef barley soup, tuna salad, whole grain bread, baby carrots, creamy coleslaw, fresh orange
December 24
Creamy Tuscan chicken, rice pilaf, winter vegetable blend, tropical fruit salad
Lighter Fare
Sliced turkey and Swiss with lettuce leaf and sandwich wrap, pickled beet salad, tropical fruit salad, sugar cookie
December 31
Roasted pork with sauerkraut, mashed potatoes, cinnamon apples, dinner roll
Lighter Fare
Waldorf chicken salad, croissant, pickled beet salad, cinnamon apple slices, gelatin with fruit
December 25
Centers Closed
January 1 Holiday
Centers Closed
December 26
Breaded fish sandwich, sandwich roll, stewed tomatoes, macaroni & cheese, creamy coleslaw
Lighter Fare
Bacon, lettuce, tomato, whole grain bread, three bean salad, pears, fresh apple
January 2
Chicken Florentine, wild rice blend, buttered lemon pepper, broccoli & cauliflower, applesauce, whole grain bread
Lighter Fare
Buffalo chicken wrap with blue cheese dressing and lettuce leaf, Mandarin oranges, celery sticks
December 27
Chili con carne, white rice, buttered vegetable blend, fresh pear
Lighter Fare
Ham salad, croissant, creamy coleslaw, peaches, sugar cookie
January 3
Pork bbq, sandwich roll, macaroni & cheese, green & wax beans, creamy coleslaw
Lighter Fare
Greek salad with breaded chicken strips, pasta salad, tropical fruit salad, fresh apple
is






method.
Levi White (13+), Archer McKee (912), and Jericho Green (5-8) were the second-place winners.
The third-place winners included Cerafina McKee (13+), Josephine Youmans (9-12), and Maylyn Lieberknecht-Holman. This event was inspired by the very successful Homeschool Art Show and Competition held last April, in which homeschool students created 400 pieces of art and our Odyssey of the Mind Homes-

chool Team. While this event was a bit smaller, it was a huge success, and it is expected to continue to grow. They are thankful to Pine Street Methodist, which has embraced the LCCHA Community and has allowed us to host numerous events in their venue.
If you are interested in homeschooling or would like to talk to someone, please feel free to contact the LCCHA Administration at info@lcchea.com or Dr. McKeon at 570-916-1376.


































































































is @ 3:30 Pm, $10,000.00 down payment day of auction w/balance due Whitin 45 days, transfer taxes will be split between seller & buyer, Realtor participation welcome call for details Contents consist of some very nice clean hand & power tools and woodworking equipment; Delta contractors deluxe table saw, Delta joiner, Grizzly 1hp dust collector, Grizzly spindle sander, Bosch Router & Router table, Craftsman drill press, Jet 10” tilting arbor saw, Jet air filtration system, Sthel chainsaws &


































































By Lou Hunsinger Jr.
In a move that many baseball observers thought was badly overdue, feared slugger Dick Allen, along with former Pirate great Dave Parker, were elected to the National Baseball Hall of Fame last week. He narrowly missed in two previous tries, including one time by just one vote. Allen joins

other Bowman Field alumni, Jim Bunning, Nolan Ryan, Bill Mazeroski, and Jim Rice, in the baseball shrine. He was elected to the Bowman Field HOF in 2010.
Allen played here with the Williamsport Grays in 1962 and was one of the Grays’ and the Eastern League’s most dominant players that year.
In 1962, Allen played in 132 games for
the Grays and batted .329, just barely being beaten out for the league’s barring title by Jim Ray Hart. He hit 32 doubles, 10 triples, 20 homers, and 109 RBIs, attained a slugging percentage of .548, and an OPS of .957. He was named to the Eastern League All-Star Team that year.
Allen was one of the speakers for the Hot Stove League banquet in 2007, and I had a chance to talk to him before the banquet.
“I really enjoyed playing here in Williamsport for the Grays in 1962. We had a great team, and the fans here were great,” Allen said. “We won the regular season pennant by something like 20 games before being beat by Elmira in the playo s.”
Allen told me that although his experience in Williamsport was, for the most part, positive, it was still sometimes hard for him and some of the other African-American ballplayers to nd a place to stay. He said they sometimes stayed at the Lycoming Hotel (now the Genetti) or found a couple of boardinghouses to stay at a er some hard searching.
Allen con rmed to me a story he had heard about three years ago from the late Rankin Johnson, former president of the Eastern League, who said that Allen asked him to contact Phillies o cials to ask permission for him to play over the winter with the Williamsport Billies team of the Eastern Professional Basketball League. He said that John Quinn, Phils’ general manager at the time, said
no because he did not want to see Allen jeopardize his career with a possible o -season injury. Allen had been a standout high school basketball player at Wampum in western Pennsylvania. He talked nostalgically and fondly of that 1962 Grays team.
“We had a wonderful manager, Frank Lucchesi when I was here,” Allen said. “He taught me a lot, as well as the rest of the guys on the team. It was a tough league that year; there were some great players playing it, especially pitchers such as Tommy John, Dave McNally, Luis Tiant, and Wilbur Wood. I was just beaten out for the batting title by Jim Ray Hart, who later starred for San Francisco, and Ken Harrelson was quite a slugger that year as well.”
Allen said the playo disappointment of 1962 gave him a foretaste of an even greater disappointment: the Phillies’ pennant race collapse in 1964 when they had a 6 1/2 game lead with about ten games to go.
I was very pleased with Allen’s election. He was one of my all-time favorite ballplayers, and you always had a sense of anticipation that he could put one out each time he appeared at the plate. He provided many great baseball thrills for many people, including those who had the pleasure of seeing him play at Bowman Field in 1962. His fans always knew he was a Hall-of-Famer, and now it is formalized.










































































































































































By Kayla Keen, RN Trauma Injury Prevention Coordinator, UPMC Williamsport
The holiday season is a wonderful time lled with family gatherings, festive decorations, and plenty of treats. But the season also brings certain risks for kids, from choking hazards to potential injuries with holiday décor. Here are some simple safe-
ty tips to keep your holiday joyful and your kids safe.
Decorations and Lights
Holiday decorations are o en bright and appealing to children, but they can also be hazardous. If you have a Christmas tree, make sure it’s securely anchored so that it can’t tip over. Ornaments should be kept out of reach, especially small ones that could be swallowed or sharp ones that could break. Glass ornaments and those







with small parts are particularly risky for young children, who might see them as toys.
Holiday lights add sparkle, but they also come with electrical dangers. Inspect all light strings for frayed wires or broken bulbs. Keep cords tucked away and ensure outlets are not overloaded. Battery-operated candles are a safe alternative to real candles, which can pose re hazards.
Safe Gi s and Toy Selection
Choosing safe toys is essential for preventing injuries. Every year, nearly 200,000 children under the age of 15 years are seen in emergency departments for toy-related injuries; more than 500 every day. Always check age recommendations on toys and follow them closely. Small parts are a choking risk for children under age three, so avoid toys with small, detachable pieces. Be cautious with button batteries found in many toys and gadgets; if swallowed, these can cause serious internal injuries. Keep toys with strings, cords, or magnets out of reach as well, as they can be strangulation or choking hazards.
such as whole grapes, nuts, and hard candies. Be cautious with sticky treats like marshmallows, as they can also be dicult for young kids to chew and swallow safely.
If your child has food allergies, be extra vigilant about what they eat at parties or gatherings. Cross-contamination is common during the holidays, so ask about ingredients in homemade dishes, and consider bringing allergy-safe snacks for your child.
If you’re traveling, ensure your child’s car seat is properly installed and suitable for their age and size. During long drives, take breaks to allow kids to stretch, eat, and stay comfortable. If you’re ying, bring plenty of snacks and entertainment to keep little ones occupied and calm.
Managing Holiday Stress

When setting up electronic gi s, follow all safety guidelines for batteries, and supervise young children when they’re using these toys. Toys with sharp edges or loud noises can also be risky and may frighten young children.



Holiday treats are a big part of celebrations, but certain foods pose choking risks. Avoid giving children under age four foods that are round, hard, or sticky,
Holidays can be overwhelming for children with all the excitement and changes to their routines. Stick to a regular sleep and meal schedule as much as possible to help kids feel more secure. Prepare your children for gatherings by explaining what to expect and be mindful of sensory overload from loud sounds and crowds. By taking simple precautions, you and your family can enjoy all the holiday season o ers and keep things merry and bright. Wishing you and your family a happy, healthy holiday!
Kayla Keen, RN, is the trauma and injury prevention coordinator for UPMC Williamsport. For more information, go to UPMC.com/NorthCentralPa.







BX1880V-1 Package
16.6 HP†, Kubota diesel engine, 4WD, HST transmission, ROPS and BX2812A 60” power angle plow. List price of $15,821.

BX2380RV-1 Package





BX23SLSB-R-1 Package


LX2620HSTC Package


23 HP†, Kubota diesel engine, 4WD, HST transmission, ROPS and BX2816 50” snowthrower. List price of $20,520.



23 HP†, Kubota diesel engine, 4WD, HST transmission, ROPS, loader & backhoe, 60” standard deck, Landpride 60” power angle plow and grapple, and LED worklights. List price of $35,684.
24.8 HP†, Kubota diesel engine, 4WD, HST transmission, cab with heat & AC and LX2963 63” snowthrower. List price of $37,539.


MX5400HST Package 57 HP†, Kubota diesel engine, 4WD, HST



















†For complete warranty, safety and product information, consult your local Kubota dealer and the product operator’s manual. Power (HP/KW) and other specifications are based on various standards or recommended practices. **Limitations under Section 179 may apply. See a qualified tax professional for advice on your specific situation.



Each year on the twenty- h day of Kislev, which typically falls during the month of December, adherents of the Jewish faith celebrate the festival of Chanukah. Although Chanukah may not bear the same religious signi cance as other Jewish holidays, it is a well-known celebration.
Chanukah commemorates the rededication of the Temple by the Maccabees in 165 BC a er its desecration by the Syrians. Although there was not enough oil le to light the Temple for even one night, lamps remained illuminated for eight straight days and nights.
us Chanukah is known as the Festival of Lights, which incorporates many unique traditions.
Lighting the menorah
Perhaps the most visible and important Chanukah tradition involves the menorah. While traditional Jewish menorahs have seven branches, the Chanukah menorah, known as the hanukkiah, actually has nine branches. ere are eight candles and a ninth, which is called the shamash, is used to light the other eight. e menorah is lit each night a er sundown.






Chanukah gelt is money given as presents during the festival. It is typically o ered to children and sometimes to teachers. Other gi s have now largely replaced the coins once o ered, and gelt is sometimes chocolate.
Playing dreidel
Greek-Syrians outlawed Jewish studies at one point, so the Jews spun dreidels to pretend they were only playing games. Really they were engaged with their scripture. e tradition of spinning the dreidel endures as a Chanukah tradition.
Foods fried in oil e miracle of the burning oil extends to the foods enjoyed during Chanukah. Many of the holiday foods are prepared in oil, including latkes (fried potatoes) and sufganiyot, which are fried, jel-


























ly-filled doughnuts. According to Town & Country magazine, millions of jelly doughnuts are consumed in Israel throughout Chanukah.
An authentic Chanukah celebration often includes traditional dishes served in the spirit of celebration and gratitude. Brisket is frequently prepared for Chanukah dinners. Brisket was adopted because it was affordable and delicious. Jewish brisket is braised, and served with carrots, potatoes and other vegetables. Brisket may be served alongside another Chanukah dish, kugel, which is a casserole made from
Although Christmas cookies may be ubiquitous this time of year, cookies often are part of Chanukah traditions as well. Some cookies are cut to look like dreidels or stars. Those who want to incorporate the miracle of oil into their baking can seek recipes that use oil in place of butter in the cookie batters, something that can make them dairyfree and also vegan.
Chanukah begins on December 25, 2024, and will last through January 2, 2025. It’s a festive time to embrace many time-honored traditions.





























By Joseph W. Smith III
Following up on last year’s list, your Webb movie-critic herewith o ers another batch of under-the-radar holiday movies for seasonal screening:
Comfort and Joy (1984) – How’s this for an unlikely premise: A popular Glasgow disc jockey, devastated by a recent break-up, somehow becomes the go-between in a turf war between two rms of competing ice-cream trucks—“Mr. Bunny” and “Mr. McCool.”
Perhaps only writer-director Bill Forsyth—o eat specialist behind Local Hero and Gregory’s Girl—could have pulled it o . Happily, he gets considerable help from a charming Bill Paterson in the lead—and a great score by Dire Straits’ Mark Knop er e Man Who Invented Christmas (2017) – Downton Abbey’s dashing Dan Stevens plays Charles Dickens in this fanciful biopic about the author’s struggle to nish Christmas Carol on deadline. As the energetic young writer juggles family and nance, he also ies about his study, arguing with characters who’ve come to life from the book.

Scrooge is beautifully played by the late great Christopher Plummer, still stealing scenes here at age 87.
e Bishop’s Wife (1947) – In this neglected second cousin to It’s a Wonderful Life, Cary Grant plays an angel helping a Manhattan bishop who’s become too focused on worldly goals.
Frankly, I couldn’t picture the suave and urbane Grant as a heavenly being—and indeed he was at rst slated to play the bishop; but the beloved star brings just the right light touch to this role.
David Niven plays the bishop, with Loretta Young as the titular spouse. Film co-stars two kids from It’s a Wonderful Life: Bobbie Anderson, who played the young George Bailey—and Karolyn Grimes, who appeared as little Zuzu.
Arthur Christmas (2011) – A Santa Claus tale for the 21st century: St. Nick has gone high-tech, with an army of North Pole elves at computers, coordinating delivery by a massive invisible aircra .
On one Christmas Eve, just as Santa is grooming his rst-born to take over the family business, the younger Arthur Claus discovers that one pres-









































ent failed to reach its intended child. Rousting his irascible grandfather out of retirement, Arthur also enlists a lovable elf, an old-fashioned sleigh and an ancient reindeer to help right the wrong. In these ways, Arthur is able to feel both futuristic and nostalgic at the same time.
Prep and Landing (2009) – “Prep & Landing,” a terri c 22-minute animated gem, plays like the Pixar short you never heard of.And indeed, except for some behind-the-scenes work from Pixar guru John Lasseter, the lm doesn’t feature any well-known names; but, as overseen by Disney Animation, it looks splendid—and the story is a joy.
Wayne the elf is a 227-year North Pole worker whose job is to go ahead of Santa prepping houses for his arrival. One year, passed over for a promotion and paired with a good-hearted rookie, Wayne decides to slack o on one home—with nearly disastrous results.
Followed by two sequels—“Operation:
Secret Santa” in 2010 and “Naughty vs. Nice” in 2011—“Prep” boasts a sleighfull of references to other holiday classics; the complete list at Wikipedia will make you want to watch it again.
Merry Christmas, Mr. Bean (1992) – If you don’t know Rowan Atkinson’s bumbling boob from the eponymous British TV show, this short Christmas episode is a good place to start.It’s one
uproarious gag a er another, beginning with Bean’s deconstruction of a department-store creche scene, and nishing with a see-it-to-believe-it turkey-dinner mishap.
ere isn’t much Christmas sentiment in this madcap farce, but Bean’s side-splitting antics make a breezy breather at this busy time of year.
Dr. Seuss’ e Grinch (2018) – I guess any lm that made half a billion bucks hardly quali es as “under the radar.” But I sense folks have already forgotten about this computer-animated winner—the third screen version of Dr. Seuss’s beloved book about the titular grouch and his attempt to steal Christmas from the good-hearted Who’s.
With its lead voiced by Benedict Cumberbatch, the movie stumbles somewhat in ditching many of Seuss’ carefully composed rhymes, substituting more straightforward voice-over by the capable Pharrell Williams; so it’s not as good as Chuck Jones’s peerless 1966 TV version. But it gives its love-to-hate misanthrope a compelling backstory; and—together with a larger role for little Cindy Lou Who—presents its viewers a ne seasonal message about how much we need each other … and how Christmas, perhaps, doesn’t come from a sleigh.
Here’s hoping your hearts grow three sizes that day.









































































































































































































•
•
•
•
•
•





The holiday season is full of faith and celebration. Even though people may believe this important time begins at the start of December, for millions of the Christians, the Twelve Days of Christmas begin with the birth of Baby Jesus on December 25 and continue through the Epiphany on January 6.
e Epiphany, also known as ree Kings Day, is a Christian feast day that “celebrates the revelation of God in His Son as human in Jesus Christ,” says e National Shrine of Saint Jude. e Epiphany is celebrated on January 6 each year and gets its name from the Greek word meaning “to reveal, or manifestation,” a nod to the idea that this was the day Jesus was revealed to the world.
On the Epiphany, three Magi visited the Christ child to pay homage. ese wise men were the rst to greet Jesus a er his parents. e Magi followed a star to Bethlehem, having faith that the Child’s location would be accurate. e unlikely royal visitors


bestowed gi s of gold, frankincense and myrrh. ese herbs are typically used in burial ceremonies, and their o ering may have potentially foreshadowed Jesus’ destiny.
According to Father Hezekias Carnazzo, a Melkite Catholic priest and founding executive director of the Virginia-based Institute of Catholic Culture, the Feast of the Epiphany is one of the earliest feasts and actually predates the celebration of Christmas.
Although the Epiphany is an important date for Christians and many celebrate it, celebrants in Spain and Latin America consider it as important as Christmas Day. Within these nations Día de los Reyes ( ree Kings











Day) is a time for serving Rosca de Reyes, an oval-shaped treat that has a small doll inside to represent Baby Jesus. e gurine symbolizes the hiding of the infant Jesus from King Herod’s troops. Children also receive the majority of their gi s on ree Kings Day. It is customary for kids to place their old shoes with a wish list on them for the ree Kings. On the morning of January 6, the shoes are lled with toys and gi s.
e Epiphany is celebrated in various ways around the world. In the
Czech Republic, people swim in the freezing cold Vltava River and men dress up as the Magi before riding camels through Prague’s city center. ree Kings Bread, similar to the Rosca de Reyes and called Dreikönigskuchen, is prepared and consumed in Germany and Switzerland.
Christmas fanfare does not cease when the calendar turns from December 25 to 26. e Epiphany on January 6 also is an important day of celebration.

ARIES – Mar 21–Apr 20
Aries, a special person in your life deserves all of your attention. Romance might be on your mind, and you’ll look forward to all of the time you can spend together.
TAURUS – Apr 21–May 21
You may feel artistically inspired this week, Taurus. Explore projects like home improvements or cra ing. ere are many things to try.
GEMINI – May 22–Jun 21
Your attendance at a wedding or another special event could have your thoughts moving in a romantic direction, Gemini. Maybe you’re thinking of taking your relationship to another level?
CANCER – Jun 22–Jul 22
Cancer, forge ahead in your e orts if you aspire to learn a new skill or take on a different project. is might involve meeting new and interesting people. Expand your social network.
LEO – Jul 23–Aug 23
Leo, it is important to put others rst this week, particularly your spouse or romantic partner. You don’t want any hurt feelings circulating right now.
VIRGO – Aug 24–Sept 22
An unexpected visitor might come your way in the next few days, Virgo. is could require overhauling your schedule and even space in your home to make room.

LIBRA – Sept 23–Oct 23
Family and friends will have a di cult time changing your mind once you have taken a stance, Libra. You have dug in your heels on this topic.
SCORPIO – Oct 24–Nov 22
Scorpio, new work assignments or additional business may complicate matters in the days ahead. at can be great during times of year when spending can get out of control.
SAGITTARIUS – Nov 23–Dec 21
As you prepare for the colder temperatures, holistic arts, acupuncture, herbs, and therapies might be on your mind, Sagittarius. You don’t want to be sick this goaround.
CAPRICORN – Dec 22–Jan 20
Capricorn, you will try to meet the demands of your need for information this week. Chances are you’ll be reading the newspaper and news outlets as much as you can.
AQUARIUS – Jan 21–Feb 18
You cannot gain traction right now, Aquarius. Perhaps you haven’t met the right people yet? Keep your eyes and ears open for new opportunities.
PISCES – Feb 19–Mar 20
Pisces, if a career change has been on your mind, the new year might be a chance to get those gears moving in the right direction.





























































































By Jon Pries








While we have had a string of relatively mild winters, we can easily recall getting slammed several winters ago with up to 30-plus inches of snow that crippled travel and many outdoor activities for days. We humans can stay indoors, start a fire in the fireplace, turn the thermostat up a bit, and make a mug of hot chocolate milk or a bowl of belly-warming soup for lunch! But what about all of Mother Nature’s creatures that may be struggling with whatever she throws at them this winter?
For the various birds that do not head south for the winter months, there is a pretty easy solution to help them make it through the snowy days ahead. Bird feeders of various designs can supply needed nutrition to these winter residents. The real question, if you are just getting started in winter bird feeding, is just what to feed.
Black-oil sunflower seed is one of the best selections to include in any seed
mix since almost any bird visiting a bird feeder will eat these seeds. The outer shell is much thinner than other sunflower seeds, and the seed itself tends to be larger; thus, the birds get more food value per seed than blackoil sunflower seeds. Those birds that cannot crack the hull will land below the feeder and scour the area for bits and pieces of the seed that other birds drop.
Thistle seeds can be a little pricey, but they are a favorite of all small finches, including gold finches, house finches, and purple finches. The seeds are generally presented in a tube feeder with small thistle-seed-sized holes.
Offering a mix of seeds is always a good idea since it will appeal to a wider variety of birds. But, be careful as some inexpensive seed mixes do contain “filler” seeds — junk seeds that many birds won’t eat. It might be better to concoct your own mix of seeds. Safflower seeds — white, thinshelled conical seeds — are eaten by many different birds and are known to be a favorite of the northern cardinal.


























Cracked corn is always a good addition to your seed mix since it appeals to most birds visiting a feeder. Don’t forget to include the black-oil sunflower seeds. If you are unsure what to include, contact a local feed store that can supply you with a variety of products for winter feeding. If pesky squirrels become a problem, you might solve the situation by offering them their own supply of corn. Merely drive spikes through a board and attach the board to the side of a nearby tree — then stick ears of corn on the spikes. Hopefully, this will lure
the squirrels away from the bird feeder. Turkeys, deer, and bears spend a great deal of time feeding during the later months of fall, frequently on acorns when they are plentiful, in order to build up a much-needed layer of fat to aid in making it through the cold of winter, when food may be scarce. In the dead of winter, you might see deer or turkeys in picked-over corn fields pawing or scratching through the snow in search of any remaining kernels of corn. Shelled corn is a popular choice of feed to put out for deer or turkeys. Remember, it is legal to put
out this feed for deer or turkeys as long as all of the hunting seasons are over.
Caution: CWD (Chronic Wasting Disease) is a disease that has reared its ugly head and is spreading slowly in Pennsylvania. It is spread from one deer to the next when they are in close proximity to one another. Thus, if you are putting corn out, it would be better to scatter it over a large area rather than just place it in a single pile or two. If you are considering a mineral mix for deer, it would be beneficial to begin the offering once the last of the deer hunting seasons are over. Providing
a mixture of minerals now will begin to benefit the deer as they gain stronger bones and will provide better milk production for the does in the spring. This long-term offering of the minerals is of great benefit throughout the year, but remember that all minerals and residue must be taken up 30 days prior to any appropriate hunting season. This winter offering of feed can be a fun activity and provide some great viewing opportunities. It will also be of great benefit to birds and animals when snow and ice limit their usual food sources.




















Irealize our regular rearms deer season is over for this year, but if you were not able to tag that deer, there are still some opportunities le .


Our statewide intlock deer season for both antlered and antlerless deer runs from Dec. 26-Jan. 20. Sure, you have to put that high-powered ri e with the scope back in the gun cabinet and get out that primitive intlock, but that doesn’t mean you can’t score.
Several years ago, I found myself perched in a treestand with my intlock, and I’ll be honest, I wasn’t expecting much. It was my rst hunt with a intlock, and my con dence level was low. I was at the inside corner of the woods overlooking a eld when
Ken Hunter
a big doe came from the other side of the eld and stopped within about 40 yards of my stand. She stood broadside, and I readied my intlock and squeezed the trigger. To my surprise, the deer dropped almost immediately. Yep, they really do work.
Even if you don’t plan to go out with a intlock, your hunting still isn’t over; squirrel hunting season continues from Dec. 1624 and Dec. 26-Feb. 28 statewide. If you are still hung up on using a scope and a ri e, then get out your .22 ri e and head out for some squirrel hunting. Years ago, I used to spend a lot of time perched on a log, watching all around me for a squirrel to move. No, it’s not the same as



deer hunting, but it’s great fun nevertheless. Squirrel hunting with a scoped .22 rifle is also a great way to teach rifle-hunting skills to a young new hunter. If a squirrel hunt doesn’t do it for you, get that shotgun out and head to some brushy tree lines and overgrown fields for rabbit hunting. Our statewide rabbit season still offers hunting from Dec. 16-24 and Dec. 26-Feb. 28. When I started rabbit hunting, I did it the hard way, walking a lot and a lot of brush kicking, but I’ll be honest: a good rabbit dog can make all the difference. Another big plus is that a few good rabbits can make for a great meal when prepared properly.
In addition to rabbit hunting, you might also want to try to bag a couple of ringneck pheasants, such as those colorful birds that used to be seen all over the
place at one time. About the only place you will find pheasants now is where the Game Commission stocks them. In recent years, I’ve been on a few hunts with some dedicated pheasant hunters who know where to go, and we’ve actually bagged pheasants on those hunts. I’ve actually limited out with two on a couple of occasions.
Grouse hunting is also in until December 24, but good luck trying to find any.
Well, if you can’t get any more hunting in over the next few weeks, we still have ice fishing to look forward to; that is, if it stays cold long enough. Over the past couple of years, the ice has started to form, and then we get those few warmer, rainy days, and there goes our ice. We’ll see. Maybe we will make it out on the ice around Christmas.




































As the strains of Auld Lang Syne ring out on New Year’s Eve, longtime Little League International President and CEO Steve Keener will enter retirement and turn over the mantel of leadership to Pat Wilson.
Appreciably, he took the time to reflect upon his experiences with Webb Weekly
WW: How satisfying has your career been?
Keener: “My career with Little League has been extremely satisfying. It’s been 44 years, and an awful lot has happened during that time. Reflecting back, when I came here in 1980, we had Little League programs in all 50 states and 19 countries. Now, we still have a presence in all 50 states but have expanded to 84 countries.
“When I think back upon the growth of the program globally, and we have had so many people involved in making that happen, it is one of the things I feel really good about. Having the opportunity for kids in 84 countries benefiting from the Little League experience, when there were just nineteen when I started, has

been rewarding.”
WW: What has meant the most to you?
Keener: “I tend to look back at the moments, and there have been so many of them, and it is hard to pinpoint anyone in particular. But personally, the one I’ll never forget because it involved my family took place at the 2001 World Series.
“We had just adopted our daughter, Maggie, and brought her here from Guatemala. She was born in an extremely poor area with no running water and no electricity. President and Mrs. Bush came for their first visit to the Little League World Series, and they asked my wife and me to host them. We explained we had a young baby girl, and Cheryl may not be able to come. President Bush said to bring the baby along.
“I remember Cheryl putting the baby down, and Maggie sort of waddled towards the President and put her hands on his knees. The President asked if he could hold her. He picked her up and began to bounce her on his knees. Maggie’s eyes began to close, and




she fell asleep on the President’s lap.
“I was sitting next to him and had goosebumps. I was thinking 13 months ago, this little precious thing was born in this god-forsaken place, and now she was taking a nap on the lap of the President of the United States. It set the framework for what has turned out to be a nice long friendship and relationship between the two of us, which led to Little League being invited to play tee-ball games on the south lawn of the White House. It is something I will always remember.”
WW: What was your biggest challenge?
Keener: “The biggest challenge I’ve faced with the program has been more recent. The whole evolution of the youth sports industry, with so much emphasis placed upon specialization and what is commonly referred to as travel ball — with many parents believing the only way their kids will be successful is if they get them into a highly competitive, rigid program playing superior competition all the time.
“The challenge has been to get people to understand that there is real value in community-based programs where kids are playing with their friends because those are the things that will become meaningful later in life. I’ve had the opportunity to meet many very successful individuals who have accomplished great things in their lives, and so many of them have told me their greatest memories come from when they played Little League.
“For 95% of the kids who have played Little League Baseball or Softball, Little League is going to be it. Only a small percentage of them are going to go on and play professionally in anything. The lessons they learn with their friends and their community at that young and impressionable time are very meaningful. To get parents to understand that has been the challenge.”
WW: How has the program changed?
Keener: “The program has changed rather dramatically. When I started, the regulations that governed local leagues were much different. There was a 20,000 population limit; you had to have a defined boundary, which sometimes meant there were sections of a community that had to have multiple leagues because of the population























number. As communities and society changed and school choice became more popular, parents wanted more freedom as to where their kids could play.
“Little League was the only organization that required a boundary area for selection to play. We needed to adapt to that. Over the years, we’ve had to make modi cations to regulations regarding eligibility. With the breakup of family units, exibility was needed to give parents a little more opportunity to choose where their kids could play.
“You don’t change just to change, but you can’t be afraid of change. In order to grow, you need to have some exibility. I am very proud that Little League today is still the industry leader in the youth sports universe.”
WW: Is there anything you would have liked to have done but couldn’t accomplish?
Keener: “I can say there are some things we’ve done that I wish we would have done sooner. In the recent past, we really put a focus on female participation as players and volunteers. Last year was the 50th anniversary of girls being allowed to play Little League Baseball, and later came the advent of the Little League So ball program. I


think we went a little too long treating so ball like it was the kid sister to Little League Baseball. Once we committed to that, the program really took o . But I think that could have been done sooner.”
WW: What are your plans for the future?
Keener: “Well. I’ve always wanted to get my golf handicap down, so I’ll have time to work on that. I really don’t have any concrete plans, and I’m not looking for a job. I’m going to take some time o . If something comes along that is of interest to me, I’ll think about it. Quite frankly, the program will be in great hands with Pat Wilson at the helm. We’ve worked together for thirty years, so he ought to know what not to do.”

















One of the joys of part-time scribing is getting to know so many great local kids involved with sports. We meet up in high school, and then we stay in touch. Sometimes, I will do a college or even a professional follow-up. Yes. It is grand. There is an impressive list. Both boys and girls from the area. This keeps me in the loop. I marvel at their successes both on and off. I will occasionally send them a few random well-dones. Many of these student-athletes get back to me with a thank you, Coach. That always makes my day.
Loyalsock’s Connor Watkins and I go back many moons. I know his family well, and I covered some of his high school games. Connor was an ALLSTATE footballer for the Lancers. The athletic dual-threat quarterback just wrapped up an impressive career. Watkins led the Villanova Wildcats to another solid year. My man put up some remarkable numbers. The senior finished with 2,102 yards passing and 13 TDS. The Wildcats were 10-4 and earned another trip to the Division 1
FCS second round. This was Connor’s third consecutive season going over 2K. He was outstanding. Fun to watch. Connor tallied 6,840 yards in the air and 49 touchdowns in college. Impressive.
“First and foremost, I want to thank God for blessing me with the opportunity to play the game I love,” Watkins said in a statement this week. “I want to express my deepest gratitude for my family and their unwavering support, sacrifice, and love. They have been my rock every step of the way.”
I wrote two stories on Connor throughout his career. My favorite was when his Villanova Wildcats were on the road playing Penn State. Connor was a redshirt freshman. He was listed as the backup quarterback. The Cats were heavy underdogs, and we were hoping for a blowout as we were hoping to see our young friend get some playing time. The Wildcats came up short on their first set of downs. Beaver Stadium was rocking as it usually does. Then I heard the PA ANNOUNCER. BACK TO PUNT FOR VILLANOVA IS CONNOR WATKINS. Say what? I

immediately grabbed my phone and started taking some photos. Dude? Connor did some punting in high school, but wow. My man was on the field early in the first quarter.
Most backups spend their Saturday afternoons on the sidelines. I later learned that Connor was a last-minute substitution. The normal punter was injured, and Connor needed to step in. Villanova is a small school, and they didn’t have much depth. Penn State’s defense was solid that year, and Connor was super busy. He had 8 punts for a net total of 277 yards with a long of 44. Not too shabby. The Nittany Lions prevailed 38-17. It didn’t matter. We were so excited for Connor. What a story.
“Coach told me to get loose,” Watkins told me a few years back. “He said something to me about kicking earlier in the week. But I didn’t know until that morning. ‘I haven’t punted since high school, Coach.’ It was something I will never forget. Stepping onto that field in front of 90,000 fans is what it
was all about. I did my best. I was there to punt. You can’t make it up. Many of my family and friends were there to show their support.
“To Villanova University, the coaching and support staff, thank you for believing in me,” Watkins continued in his statement. “You helped me grow as a player and as a person. Your guidance and mentorship have been invaluable and appreciated. Thank you to my teammates. Thank you for the brotherhood, the memories, and the countless battles we tackled together. I also want to thank the fans and those behind the scenes. Your dedication never went unnoticed. I am truly grateful.”
“With that said, I am excited to announce that I am declaring for the NFL draft,” Watkins concluded. “This is the culmination of a lifelong dream, and I am excited to see what the future brings. Thank you, NOVA nation, for your endless support. Once a Wildcat, always a Wildcat.”
Congratulations, my friend. I’m super proud of you and your achievements both on and off the field. Best wishes moving forward. I’m excited, too. Fantastic stuff, brother. We all enjoyed following you. Cheers, kid.


When things don’t move, rotate, or bend like they used to, choose the experts at UPMC Orthopaedic Care to get you back to living.
From minimally invasive joint replacement surgery to specialized foot and ankle care and individualized sports medicine services — we’re pioneering new treatment options to get you back to the things you love.
To schedule an appointment or to learn more, visit UPMC.com/YourMoveNCPA.








AKC FEMALE SHIH-TZU Puppy. Ready To Go Now. 570692-1472. 188045
1 FEMALE POMAPOO
PUPPY. Available Now, Loganton Area, $250.00. 570-2176663. 188036
FOR SALE, 3 AKC Weimaraner Male Puppies, 2 Blue, 1 Silver/Grey. Born Oct. 21, 2024. Ready For Christmas December 16, 2024. Very Friendly. Shots, Wormed, Vet Checked. Call 570-538-5739 For Price And More Information. 188038
ADORABLE YORKIE
MALE. ACA Registered. One Year Old. Started On Potty Training. Available Now
$545.00 OBO. 570-367-1851. 188048







EXTREMELY CUTE MAL-
TIPOO Puppies Available For Adoption. Parents On Premises. Call to Set Up A time To Meet Them. Males $145.00. Females
$195.00. 570-367-1851. 188047
10 WEEK OLD, Very Sweet Yorkie, Male, Available For Adoption. AKC Registered, Up To Date On Shots And Dewormer. Parents On Premises. Ready For His New Home Now, $675.00. 570-367-1851. 188046
GERMAN SHORTHAIRED POINTER X POMSKI Puppies, 8 Weeks Old, $25.00. 570-2205589. 187883
AKC FEMALE GOLDEN RETRIEVER Puppies for Sale. Lock Haven. 570-295-1304. 187884
BLUE HEELER CROSS
PUPPIES For Sale. Had shots, Wormed. Very Cute. Ready To Go $50.00. 570-437-2170. 187897



MINI BERNEDOODLE
PUPPIES For Sale. Very Cute And Smart. No Shedding. Should Mature To Around 25 Lbs. Ready Now, $350.00 Each. 570-745-3411. 187900
RED MINI POODLE PUPPIES. Shots And Dewormed. Ready To Go December 24th Just In Time For Christmas. Children Friendly, $275.00 Each. 570-725-2394 Extn:3 . 187902
KITTENS
KITTENS FREE TO A Good Home. Text Or Call 570-9711375. 188061
2 CUTE LITTLE KITTENS Looking For Their Forever Home. 1 Black And 1 Black & White. Call Sheila 972-9795630. 187765
AKC GERMAN SHORTHAIRED POINTER Female. Liver Ticked, Born 6/4/21, $300.00. 570-547-1656. 187752
















HAND FED PARROTSCockatiels, Caiques, Conures, C/T 570-995-1782 For Up-ToDate Info Or Visit ashers-exotics.com . 187886
ROUND PENS ALL SIZES Livestock Panels. Immediate Delivery. 570-916-3309. 188057
ADVERTISE your Yard Sale, Garage Sale, or Rummage Sale! Only $7.95 for 5 lines! Contact Jaimie Today!! Call Webb Weekly at (570) 326-9322 or email classifieds@webbweekly. com
MARY’S MARKET 9873 Route 220 Jersey Shore. Come Check Us Out. Fall & Winter Hours, Thursday Through Sunday 10-5pm. 570-259-1886. 188054












HESHBON PARK UNITED METHODIST CHURCH 2898 Heshbon Road, Williamsport (Turn Off Of Lycoming Creek Rd)
Pastor Jane O’Borski. Worship 9AM, Sunday School 10:15 AM. 186745
GENERAL MERCH.
EDENPURE HEATER, Full Size. Call 570-322-3256. 188053
RECORD PLAYER 3-Speed, 2 Records Included, $40.00. 570323-2363. 188042
DOLLS DOLLS FOR CHRISTMAS PRESENTS! New In Box, Name Brands, Reasonable. Some Jewelry. Call 570-433-3434. 187528
OSTER STAND MIXER, Like New, $75.00. 1950’s Vintage Royal Quiet De Luxe Typewriter, $125.00. Wooden Vintage Child Highchair, $100.00. 570-547-2205. 188029

DOLLS DOLLS FOR CHRISTMAS PRESENTS! New In Box, Name Brands, Reasonable. Some Jewelry. Call 570-433-3434. 187528 METAL ROOFING-A Real Roof for your House, Garage, Barn, also for Siding & Interior Liner. Seconds at Discounts prices. Made in Ephrata PA. Email sales@7174455222.com 717445-5222. M11

DO YOU KNOW WHAT’S IN YOUR WATER? Leaf
Home Water Solutions offers FREE water testing and whole home water treatment systems that can be installed in as little as one day. 15% off your entire purchase. Plus 10% senior and military discounts. Restrictions apply. Schedule your FREE test today. Call 1-866-996-1526. M11
PREPARE FOR POWER
OUTAGES TODAY with a
Generac Home Standby Generator. Act now to receive a FREE 5-Year warranty with qualifying purchase. Call 1-855-465-7624 today to schedule a free quote. It’s not just a generator. It’s a power move. M11
SAFE STEP. North America’s #1 Walk-in tub. Comprehensive lifetime warranty. Top-of-theline installation and service. Now featuring our free shower package & $1600 off - limited time! Financing available. 1-855-417-1306. C11
SAFE STEP. North America ’s #1 Walk-In Tub. Comprehensive lifetime warranty. Top-ofthe-line installation and service. Now featuring our FREE shower package and $1600 Off for a limited time! Call today! Financing available. Call Safe Step 1-833356-1954. M11

PREPARE FOR POWER OUTAGES TODAY with a GENERAC home standby generator $0 Down + Low Monthly Pmt with a free Quote – Call now before the next power outage: 1-855-948-6176. C11
BATH & SHOWER UPDATES in as little as 1 day! Affordable prices - No payments for 18 months! Lifetime warranty & professioanl installs. Senior & military discounts available. 1-877-543-9189. C11
CHRISTMAS TREES
BLUE SPRUCE. I Have Some Left. $10-$20.00. Tag Now, Cut Later. Call Mike 570-745-7195 . 187486
FIREWOOD
FIREWOOD. Red And White Oak. Cut. Pick-Up Or Delivery. Discount For Multiple Loads. Call 570-220-5227. 188049 FIREWOOD FOR SALE
Mixed Hardwoods, Cut 16” & 18” Lengths. $200.00 A Cord. Delivery Available, Mill Hall. 570-927-0587. 187874
SEASONED OAK & MAPLE
$200.00 A Cord. 570-279-1679 or 570-971-7447. Cash Only. 187763
SEASONED OAK FIREWOOD, Cut And Split. $200.00 A Cord, Loganton. 570-2177219. 187371
BRINSER’S LANDSCAPING: Red Oak Firewood Logs For Sale. You Cut And Split 570-560-0502
FIREWOOD FOR SALE All Split Hardwood Cut In Lengths 16, 18, 20, 22 or 24 Inches. Delivered To Your Location
$200.00 Per Cord With Additional $50.00 Per Cord If You Would Like It Stacked. Please Call 570-323-9595. 187522
LYMAN DEER STALKER
Flintlock, 50 Caliber, $500.00. Traditions Buckskinner Flintlock, 50 Caliber, $325.00. 570220-1005. 188033
TRADITIONS DEERHUNTER 50 Caliber Flintlock, $325.00. Text/Call 570-3372312. 188037
BROWNING FIELD 12
GAUGE Engraved, Mint
$625.00, Ithaca 37-12 Gauge
$575.00, Winchester 120 Ranger 12 Gauge $375.00, Mossberg 835 Camo 12 Gauge, Extra Rifled Barrel $525.00, Remington 870 Express 12 Gauge $475.00, Remington Wingmaster 20 Gauge $450.00, And More. Maybe Trades. Text/Call 272234-1161. 188052

ATTENTION OXYGEN THERAPY USERS! Inogen
One G4 is capable of full 24/7 oxygen delivery. Only 2.8 pounds. Free info kit. Call 877-929-9587. C11
DENTAL INSURANCE-Physicians Mutual Insurance Company. Covers 350 procedures. Real insurance-not a discount plan. Get your free dental info kit! 1-855526-1060 www.dental50plus. com/ads #6258. C11 M H , America’s pre-
STROKE AND CARDIOVASCULAR DISEASE are leading causes of death, according to the American Heart Association. Screenings can provide peace of mind or early detection! Contact Life Line Screening to schedule your screening. Special offer - 5 screenings for just $149. Call 1-866-518-8391. M11
DON’T LET THE STAIRS LIMIT YOUR MOBILITY!
Discover the ideal solution for anyone who struggles on the
DENTAL INSURANCE from Physicians Mutual Insurance Company. Coverage for 350 plus procedures. Real dental insurance - NOT just a discount plan. Do not wait! Call now! Get your FREE Dental Information Kit with all the details! 1-877-5531891 www.dental50plus.com/ macnet #6258. M11
DON’T LET THE STAIRS LIMIT YOUR MOBILITY! Discover the ideal solution for anyone who struggles on the stairs, is concerned about a fall or wants to regain access to their





WANTED TO BUY CALLAHAN’S ANTIQUITIES
381 Broad St., Montoursville, PA. ALWAYS BUYING
Quality Antiques, Gold, Silver Top Prices Paid With Immediate Payment.
One Piece or Whole Estates.
“Member of Certified Appraisers Guild of America”.
Open Thursday, Friday, & Saturday 11 a.m. to 5 p.m. 570-368-2597. 187548
USED WAGON RUNNING
GEARS Wanted. Call 570-4373264. 187547
Sonic Ascension Records Is Buying Albums And 45’s. Rock, Blues, Jazz, Punk & Metal.
No Collection Too Big Or Small. Cash Paid On The Spot! Call 570-360-3486
Or Find Us On Facebook. 187741 EMPLOYMENT
PART-TIME CLEANER
NEEDED Approximately 16 hours per week. Pay: $16.50 per hour. Apply to: Lewis Lumber Products, LLC, P.O. Box 356, Picture Rocks, PA. 17762-0356. www.lewislp.com/join-ourteam/ (570)584-4460 . 188040

THE JAMES V. BROWN
LIBRARY SEEKS a customer-oriented, energetic, and technology-savvy full-time Public Service Assistant II (PSA) to join our team. This position serves as the front line of customer service at the Library and provides warm, friendly, efficient, and effective support to Library users. The position pays $14-$16/hour, plus benefits. Visit jvbrown.edu/ careers for the weekly schedule, application instructions, and a complete job description. 188028
A VERY WELL ESTABLISHED (since 1939) Williamsport, Pennsylvania law firm is seeking to hire general practice, civil litigation, municipal law and school law attorneys. We litigate in both state and federal courts. The preferred candidates have excellent academic credentials and some experience. Our team of experienced attorneys and staff practices in a very pleasant, professional and rewarding work
environment. We offer top tier compensation and benefits and the opportunity for rapid career and economic advancement. Apply to McNerney, Page, Vanderlin & Hall, Attention: Thomas C. Marshall, Managing Partner, 433 Market Street, Williamsport, Pa 17701. tmarshall@mpvhlaw. com 570-326-6555. 187531
BUSINESS SERVICES
CLEANING AND HAULING
INSIDE AND OUT. We Will Clean Up And Haul Away Your Unwanted Items From Your Yard, Attic, Basement And Garage. Reliable And Reasonable. Call Gary 570-244-1424 OR 570-321-9472. 187908
HANDYMAN Fast Service, Nice Work. Call Me And Save. Mike 570-506-4669. 187901
CUSTOM LUMBER SAWING. Bring Your Logs Or I Can Use Mine. Sam Beiler 1647 Quarry Rd Jersey Shore, Pa. 17740. 570-745-2319. 187895
RICHARD’S LAWN CARE AND LANDSCAPING. Snow Plowing. PA064570. 570-7721588. 187893
RICHART’S FURNITURE
REFINISHING AND REPAIR We Make Spindles, We Fix Most Any Loose Chairs. We Also Paint Metal, 570-584-3215. 187369
YARD WORK, CLEANUP. Brush Removal, Mulching, Hauling, Weed-Whacking. Also, Clean-Outs. Fully Insured. 570439-1934. 187242
ELIMINATE GUTTER CLEANING FOREVER! LeafFilter, the most advanced debris-blocking gutter protection. Schedule a FREE LeafFilter estimate today. 20% off Entire Purchase. Plus 10% Senior & Military Discounts. Call 1-855791-1626. M11
G & W SOUND. DJ Music For Any Occasion Small Or Large. 570-220-5512

JACUZZI BATH REMODEL can install a new, custom bath or shower in as little as one day. For a limited time, waiving ALL costs! (Additional terms apply. Subject to change and vary by dealer.) Offer ends 12/29/24 Call 1-844-826-2535. M11 HOME BREAK-INS take less than 60 seconds. Don’t wait! Protect your family, your home, your assets now for as little as 70¢ a day! Call 855-401-1151. C11
WATER DAMAGE CLEANUP & restoration: A small amount of water can lead to major damage and mold growth in your home. Our trusted professionals do complete repairs to protect your family and your home’s value! Call 24/7: 1-888872-2809. C11
AGING ROOF? New Homeowner? Got Storm Damage? You need a local expert provider that proudly stands behind their work. Fast, free estimate. Financing available. Call 1-888878-9091. C11
REPLACE YOUR ROOF with the best looking and longest lasting material-steel from Erie Metal Roofs! Three styles and multiple colors available. Guaranteed to last a lifetime! Limited Time Offer -- up to 50% off installation + Additional 10% off install (for military, health workers & 1st responders.) Call Erie Metal Roofs: 1-855-338-4807. M11
JACUZZI BATH REMODEL can install a new, custom bath or shower in as little as one day. Limited times, we’re waiving all installation costs! (Additional terms apply). Subject to change and vary by dealer. Offer ends 6/30/24 Call 1-844-501-3208. C11



































Responsibilities include performance of general maintenance and upkeep of school buildings, equipment and grounds, with some minimal requirement for new construction. Salary range is $45,800 to $51,800/year. Excellent benefits package, background clearance costs reimbursed and generous leave time offered. Visit www.wasd.org/apply for application and job description.
Deadline to apply is January 3, 2025. EOE
Williamsport Area School District • 2990 West Fourth St., Williamsport, PA 17701
BECOME A PUBLISHED AUTHOR. We want to read your book! Dorrance Publishing trusted since 1920. Consultation, production, promotion & distribution. Call for free author`s guide 1-877-729-1920 or visit dorranceinfo.com/ads .C11
ELIMINATE GUTTER CLEANING FOREVER! LeafFilter, the most Advanced Debris-Blocking Protection. Schedule FREE LEAFFILTER Estimate today. 15% Off Entire Purchase. 10% Senior & Military Discounts. Call 1-833-610-1936. C11 REPLACE YOUR ROOF with the best looking and longest lasting material-steel from Erie Metal Roofs! 3 styles & multiple colors available. Guaranteed to last a lifetime! Limited Time Offer up to 50% off installation + Additional 10% off install (military, health & 1st responders.) 1-833-370-1234. C11
BECOME A PUBLISHED AUTHOR. We want to Read Your Book! Dorrance Publishing-Trusted by Authors Since 1920 Book manuscript submissions currently being reviewed. Comprehensive Services: Consultation, Production, Promotion and Distribution Call for Your Free Author`s Guide 1-866-482-1576 or visit http://dorranceinfo.com/macnet. M11
WE TRANSFORM YOUR KITCHEN IN LESS TIME, with less stress, at an amazing value. Since 1979, Kitchen Magic, a family-owned business offering cabinet refacing, new cabinetry, and luxury countertop throughout the Northeast. Call today for a free estimate 1-844-887-5145 (PA017137) M11
HEALTHCARE CLEANING NEED A CLEAN HOUSE FOR THE HOLIDAYS? No Time? Call ME! I Will Get Your Home Looking Great So You Can Relax! Great Rates, References Available Upon Request. For An Estimate Call Joyce 570-238-1796.
NO TIME TO CLEAN? If You Are Busy With Life And Cleaning Your House Is Just Too Much, Call Me And I Will Take Care Of It For You! Years Of Experience And References Too. Call To Discuss Rates And Services 570-220-3664
INFLATION IS AT 40 YEAR HIGHS. Interest rates are way up. Credit Cards. Medical Bills. Car Loans. Do you have $10k or more in debt? Call NATIONAL DEBT RELIEF and find out how to pay off your debt for significantly less than what you owe! FREE quote: Call 1-866-2720492. M11
WESLEY FINANCIAL GROUP, LLC Timeshare Cancellation Experts Over $50,000,000 in timeshare debt & fees cancelled in 2019. Get free info package & learn how to get rid of your timeshare! Free consultations. Over 450 positive reviews. 833-308-1971. C11

The Williamsport Area School District is accepting applications for Full-Time & Part-Time Custodians, second shift, Monday through Friday. Full-Time rate is $20.79/hr. and Part Time rate $19.37/hour. Must have valid driver’s license. Background clearances are required prior to hiring, but costs are reimbursed after one year of employment. Please visit www.wasd.org/employment for application and job description. EOE
Williamsport Area School District • 2990 West Fourth St., Williamsport, PA 17701
DIRECTV OVER INTERNET - Get your favorite live TV, sports and local channels. 99% signal reliability! CHOICE Package, $84.99/mo for 12 months. HBO Max and Premium Channels included for 3 mos (w/ CHOICE Package or higher.) No annual contract, no hidden fees! Some restrictions apply. Call IVS 1-866-629-6086. M11
DIRECTV Stream - Carries the most local MLB Games! Choice Package $89.99/mo for 12 mos Stream on 20 devices at once. HBO Max included for 3 mos (w/Choice Package or higher.) No contract or hidden fees! Some restrictions apply. Call IVS 1-866-859-0405. C11
12 X 60 HOUSE TRAILER
Good Condition, $10,000. 570725-2077 Ext:2 . 187553
WILLIAMSPORT- NICHOLS COURT APARTMENTS, WE ARE NOW ACCEPTING APPLICATIONS FOR 1- AND 2-BEDROOM APARTMENTS MUST BE 62 YRS. OR OLDER & MEET FEDERAL PROGRAM REQUIREMENTS. RENT INCLUDES ALL UTILITIES. SECTION 8 VOUCHERS ACCEPTED AND BUS STOPS AT BUILDING. NON-SMOKING BUILDING. THIS INSTITUTION IS AN EQUAL OPPORTUNITY PROVIDER AND EMPLOYER. PLEASE CALL 1-800-735-3068, TTD: 711 TO REQUEST AN APPLICATION. 188043

WE BUY HOUSES for cash as is! No repairs. No fuss. Any condition. Easy three step process: Call, get cash offer & get paid. Get your fair cash offer today by calling Liz Buys Houses: 1-844877-5833. C11
NOW ACCEPTING APPLICATIONS!! IRIS COMMONS APARTMENTS. Office located at 618 Center Street, Williamsport, PA 17701. 1-800-7353068 TDD: 711. 2, 3 & 4 BR Apartments. Rent includes heat. Tenant responsible for electric, water, sewer, trash removal. Must meet federal program requirements. Section 8 Accepted. Call and request an application at 1-800-735-3068. This institution is an equal opportunity provider and employer. 188044

WE BUY HOUSES Any Condition/Any Situation. No Hassles, Quick Cash. Call 570-9891938 . 187549
AMERICAN LOG HOMES DEVELOPER LIQUIDATION SALE! Log Home kits selling for Balance Owed. Up to 50% off. Design plans can be modified!No time limit on delivery. Call 1-866-307-5491, M-F 9am5pm ET. C11







If you need to acquire a passport or Hazmat endorsement Chemcoat will assist you. Our driver’s operate tractors that are 4 years old or less. We offer an excellent benefit package including Health, Eye and Dental coverage. We also have a life insurance program and a 4011< program with a match, as well as time off pay available after your 90-day probation period. Chemcoat has a monthly profit-sharing bonus.
The benefits of working for a small family-owned business will become apparent as you enjoy the family atmosphere during our holiday luncheons, company picnic to name a few.
If you would like to become a part of our family, please send your resume to pkiessling@chemcoat.com or stop in to the main office and complete an application.
We are located at 2790 Canfields Lane Montoursville, PA 17754. 570-368-8631

or

























1 & 2 BEDROOM LUXURY APARTMENTS Downtown Williamsport. Fully Furnished. All Utilities, Wi-Fi And Parking
Included. Private Rooftop Patio Deck. All Linens And Kitchen Accessories Included. Flexible Leases. No Pets, No Smoking. $1,200 & $1,400/Month. 570916-3309. 188056









REDUCED CHRISTMAS SPECIAL, 2006 KAWASAKI VULCAN 900 Motorcycle. Very Good Condition. $2,500.00. 570220-2582. 188030 TRACTORS

WANTED! MOTORCYCLES! ANTIQUE AND CLASSIC. Honda, Kawasaki, Suzuki, Yamaha, Triumph, BSA, and other foreign models. $$PAYING CA$H$$ 717-5778206 KRMiller1965@yahoo. com . M11
1 BEDROOM, LARGE ROOMS. Near Bus Stop, All Appliances, Parking. No Pets. No Smoking. 570-916-3309. 188060
3 BEDROOM 2ND & 3RD Floor. Near Bus Stop, All Appliances, Parking. No Pets. No Smoking. 570-916-3309. 188059
COMMERCIAL UNITS
7,000 SQ. FT. STORE FRONT COMMERCIAL At 4th And Diamond Street, Newberry. 2 Bathrooms, $2,500.00 Monthly. Gas Heat, Very Reasonable Utilities, Air Conditioned, Parking. 570-916-3309. 188058
STORAGE UNITS
10 X 16. $75.00/Month. Call 570-337-4994. 187550
VEHICLES
SELL YOUR VEHICLE FAST! WEBB WEEKLY CLASSIFIED ADS GET RESULTS. DIRECT MAILED TO OVER 58,000 HOMES AND BUSINESSES. TAKE ADVANTAGE OF OUR SPECIAL, 3 LINES FOR 4 WEEKS, ONLY $15.95. CALL CLASSIFIED DEPARTMENT AT 570-3269322

NH 4835 TRACTOR $14,900.00. Also Do Repairs On Engines, Transmissions, Etc. Burkholder’s Equipment Sales, LLC 814-720-8845. 188055
2021 Jayco Jay Flight SLX, 212QB, Used twice, Extras. $14,500. Call: 570-998-2656. 187518
VEHICLES WANTED
BUYING CLASSIC CARS, TRUCKS, SUVs **American and Foreign** Any Condition. Buying entire car collections. $$PAYING CA$H$$ Please call 717-577-8206 KRMiller1965@ yahoo.com . M11
DONATE YOUR CAR, TRUCK, boat, RV and more to support our veterans! Schedule a FAST, FREE vehicle pickup and receive a top tax deduction! Call Veteran Car Donations at 1-877327-0686 today! M11








GET A BREAK ON YOUR TAXES! Donate your car, truck, or SUV to assist blind and visually impaired. Arrange a swift, nocost vehicle piclup and secure a generous tax credit for 2025. Call Heritage for the BlindddToday at 1-844-320-2804 today! M11
DONATE YOUR CAR TO VETERANS TODAY! Help and Support our Veterans. FastFREE pick up. 100% tax deductible. Call 1-800-245-0398. C11 ATTENTION B & C Auto Wreckers Will Now Pay Top Dollar For Your Unwanted Cars, Trucks and Equipment. Licensed and Professional Service. Call For Details. 570-547-1040. 187551
























































































